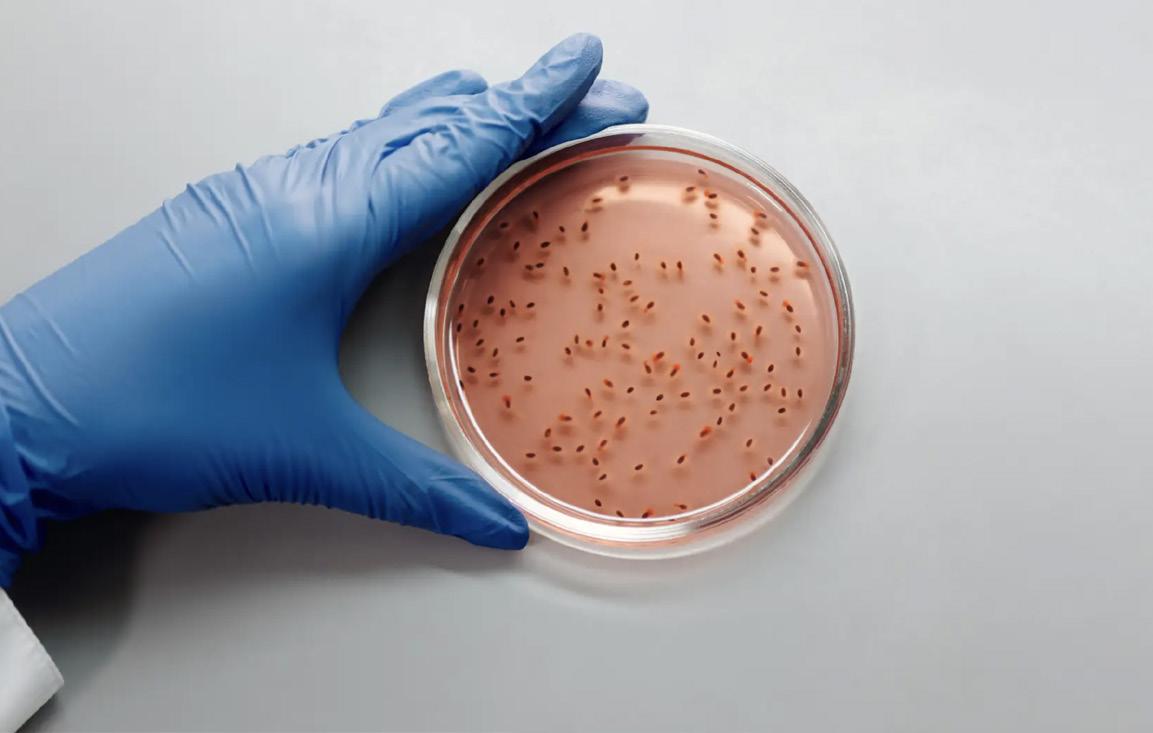

Desmiente AMLO que el Ejército no entregara el informe completo sobre Ayotzinapa


Exitosa participación de la población en el Segundo Simulacro Nacional 2023




Asiste Javier Jiménez al segundo Informe de Gobierno en Tapachula


Hoy Claudia Sheinbaum visita Tuxtla para continuar con la defensa de la 4T


Rutilio Escandón inaugura construcción de Unidad Deportiva en Venustiano Carranza

JUEVES 21 DE SEP TIEMBRE DE 2023 · AÑO 12 · Nº. 4414 32 PÁGINAS · VALOR $7.00 WWW.SIE7EDECHIAPAS.COM Los acervos también sirven para valorar
pluriculturalidad de los pueblos Ser responsables, la clave para ser felices 3 Para que Chiapas crezca, Patricia Armendáriz es la respuesta 7 Chiapas reafirma su compromiso en unidad y movilización
Dr. Pepe Cruz se mantiene con mayor preferencia para ser gobernador de Chiapas
la
8 27 6 3 ENCUESTA CATHERINE BLOCH ESTAR CONSCIEN7E 4
25
9
“LA ESPERANZA NOS UNE” 7
Parece

que redes sociales limita la libertad de expresión
Es común en nuestros días (y más acercándose a tiempos de procesos y campañas electorales) que exista un amplio debate tanto en medios de comunicación masiva, como en redes sociales y de entretenimiento en Internet, sobre asuntos de interés público, y entre ellos se susciten acaloradas discusiones sobre funcionarios públicos, aspirantes y candidatos a cargos de elección popular, dirigentes de partidos políticos, y figuras públicas en general relacionadas con la política. Particularmente, en redes sociales, encontramos la posibilidad de interactuar y publicar nuestros puntos de vista, a diferencia de los medios tradicionales como la radio y televisión. Esta actuación libre permite que en muchas ocasiones se puedan emitir opiniones a veces desagradables para algunas personas, no solo en el tema de sus actuaciones públicas, sino en su actuar como figura pública. Ahora bien, si observamos el actuar de diversos usuarios en las redes sociales más comunes (Facebook, X antes Twitter, YouTube, por ejemplo) vemos que los comentarios en ocasiones atacan de una manera agresiva no solo al desempeño de las personas, sino incluso a sus características físicas, orientaciones ideológicas, religiosas y de género, de pertenencia a grupos humanos o sociales, entre otras. Muchas veces, por desconocimiento de los usuarios, éstos se amparan bajo el ejercicio de la libertad de expresión para emitir estos comentarios, justificando que son libres de decir lo que piensan y que, tratándose de Internet, es un espacio libre sin restricción. Si bien nuestra Constitución Política consagra en sus artículos 6 y 7 los ejes rectores de la libertad de expresión, entre ellos que la manifestación de las ideas no puede ser objeto de ninguna inquisición judicial o administrativa, también establece supuestos específicos de excepción a su ejercicio, como el ataque a la moral, la afectación a los derechos de terceros, la provocación de un delito o la perturbación del orden público. Asimismo, en el marco internacional de derechos humanos, tales como la Declaración Universal de Derechos Humanos, el Pacto Internacional de Derechos Civiles y Políticos, y Convención Americana sobre Derechos Humanos, entre otros instrumentos, encontramos que existen límites a la libertad de expresión, tales como la prohibición de propaganda en favor de la guerra y toda apología del odio nacional, racial o religioso que constituyan incitaciones a la
Directorio General

FRANCISCO GRAJALES PALACIOS
violencia o cualquier otra acción ilegal similar contra cualquier persona o grupo de personas, inclusive los de raza, color, religión, idioma u origen nacional; el respeto a los derechos o a la reputación de los demás; o la protección de la seguridad nacional, el orden público o la salud o la moral pública. De igual forma, los organismos internacionales especializados en libertad de expresión han señalado que respecto a Internet, si bien constituye una herramienta para favorecer la participación política de la ciudadanía, sobre todo en aquellos países donde existen un control de los medios de comunicación, también es cierto que han destacado que por regla general debe mantenerse la apertura y el libre flujo de información, y excepcionalmente se admitirán limitaciones, ajustadas a los criterios de la normativa internacional de los derechos humanos, entre ellas por supuesto el respeto a los derechos de terceras personas. Por otra parte, no se debe olvidar que las plataformas de internet son fundamentalmente propiedad privada, y quedan sujetos a sus propios lineamientos de comunidad, o términos de servicio, que en esencia replican el marco general de límites de libertad de expresión que hemos señalado. Por ello, si bien se acepta que, en un sistema democrático, se procura un debate desinhibido y crítico, también es cierto que debe protegerse y cuidarse la dignidad de las personas. En consecuencia, no podemos establecer que la libertad de expresión es ilimitada, y que se puede decir lo que sea en espacios de Internet, ya que no se puede atentar contra la dignidad de una persona o un colectivo humano. Si bien en tiempos electorales la crítica puede ser desinhibida, abierta y vigorosa, nunca debemos olvidar que ya sea un ciudadano común, una figura pública, un político, un “influencer”, “youtuber” o cualquier creador de contenido, o un simple comentarista a una publicación digital, no puede olvidarse del respeto a la honra, a la imagen, y al reconocimiento de la dignidad. Por ello, existen los mecanismos administrativos y judiciales para proteger a las personas y en su caso sancionar a los infractores y restituir los derechos afectados contra esos ataques injustificados, que nada abonan a la democracia y la convivencia en sociedad; y siempre hay que recordar que los derechos de cada persona están limitados por los derechos de las demás personas.
Presidente del Consejo. (direccion@sie7edechiapas.com.mx)
GASTÓN IVÁN MÜLLER
Director General. (director@sie7edechiapas.com.mx)
CRISTINA GRAJALES CARRILLO
Editor Responsable. (redaccion@sie7edechiapas.com.mx)
CLARIBEL GRAJALES CARRILLO
Representante Legal. (legal@sie7edechiapas.com.mx)

El Sie7e es impreso y distribuido por El Sie7e de Chiapas de S.A de CV. Numero de Certificado de Reserva otorgado por el instituto Nacional de Derechos de Autor: 04-2021-092016494100-101. Número de Certificado de Licitud de Título y Certificado: 16746.
Calle 12 de Octubre, colonia Bienestar Social, entre México y Emiliano Zapata. C.P. 29077. Tuxtla Gutiérrez, Chiapas. Tel: 01 961 12 137 21 direccion@sie7edechiapas.com.mx Los firmantes son responsables de sus articulos. Jueves 21 de septiembre de 2023 · Año 12 · Nº 4414 Queda prohibida su reproducción parcial o total sin la autorización de esta casa editorial y/o editores.
El Internet constituye una herramienta para favorecer la

Editorial EL COCO DE TODAS LAS VOCES
Estado
Dr. Pepe Cruz se mantiene con mayor preferencia para ser gobernador de Chiapas
COMUNICADO-EL SIE7E FOTO:CORTESÍA
Tuxtla.- Según la empresa encuestadora Massive Caller, la persona que ha logrado mantenerse a la cabeza de las preferencias rumbo al proceso electoral 2024 para elegir Gobernador de Chiapas es el doctor Pepe Cruz, quien se sostiene en la primera posición como el candidato con mayor aceptación entre la ciudadanía.
De acuerdo con los resultados dados a
conocer en las últimas horas por esta empresa especializada, es la tercera encuesta que de manera consecutiva el doctor Pepe Cruz aparece con una amplia ventaja sobre su más cercano contrincante, tanto en la pregunta donde compite con los demás aspirantes de Morena, como en aquélla donde se confronta con los candidatos de otros partidos.
Esta misma tendencia se observa en la preferencia de las personas encuestadas con relación al partido político o coa-
lición por el que votarían, donde Morena ratifica también una contundente ventaja con un 51.2% de aceptación, mientras que la alianza PAN-PRI-PRD registra tan solo el 16.4%.
Con base en estos resultados que arrojó la más reciente encuesta elaborada por la empresa Massive Caller, Morena y el doctor Pepe Cruz siguen perfilándose como la fórmula ganadora en Chiapas rumbo a las elecciones del próximo año. Concretamente, en la pregunta de “¿Quién le gustaría que fuera el candi-
DIPUTADA FEDERAL
Para que Chiapas crezca, Patricia Armendáriz es la respuesta
COMUNICADO-EL SIE7E FOTO:CORTESÍA
Tuxtla.- La empresaria y diputada federal dio a conocer su decisión de inscribirse al proceso de selección de la coordinadora estatal de defensa de la 4T; hay que dar continuidad y consolidar el trabajo iniciado por el Dr. Rutilio Escandón Cadenas
La diputada federal Patricia Armendáriz dio a conocer su decisión de participar en el proceso de selección de la coordinación estatal de los Comités de Defensa de la Cuarta Transformación
A través de un video en sus redes socia -
les, la legisladora comiteca dijo estar preparada para que la transformación de las conciencias continúe en el estado.
La también empresaria sostuvo que los chiapanecos deben ser escuchados y recuperar la conciencia individual y moral de no mentir, no robar y no traicionar al pueblo.
Patricia Armendáriz consideró que los chiapanecos debemos unirnos a esta gran transformación de la vida pública y privada de la que Chiapas ya está siendo beneficiado, pues estamos creciendo al 7 por ciento en el periodo de Rutilio Escandón Cadenas.
“Tenemos que seguir profundizando la transformación para que finalmente alcancemos nuestros sueños de una vida donde se nos trate con más justicia, más igualdad, más oportunidades, más inclusión. Nuestra líder Claudia Sheinbaum llegará mañana a Chiapas a inaugurar este gran movimiento de un paso adelante en la transformación de Chiapas.”

Finalmente, y para conocer todo el trabajo y gestiones que la diputada Patricia Armendáriz ha hecho por el estado, se le invita a todo el pueblo de Chiapas a presenciar su Informe de Actividades del Segundo Año Legislativo. La cita es este
dato (de Morena) para gobernador?”, el doctor Pepe Cruz prácticamente duplica en porcentaje a su más cercano competidor, registrando 24.8 % y 12.8 %, respectivamente.
Mientras que en la pregunta “Si el día de hoy fueran las elecciones para elegir gobernador de Chiapas, ¿por cuál de los siguientes partidos o candidatos votaría usted?”, el doctor Pepe Cruz alcanza un contundente 48.2%, en tanto que el abanderado de la alianza PAN-PRI-PRD obtiene tan solo el 9.3%.

Jueves 21 de septiembre de 2023 www.sie7edechiapas.com
ENCUESTA
25 de septiembre, en punto de las 12 horas en el Tecnológico Nacional de México, Campus Comitán, o seguir la transmisión en video a través de sus redes sociales oficiales.
Brito Mazariegos destaca visita de Claudia Sheinbaum a Chiapas
COMUNICADO-EL SIE7E FOTO:CORTESÍA
Tuxtla.- El Diputado Federal, Ismael Brito Mazariegos se sumó a las voces de bienvenida para la coordinadora de los Comités de la Defensa de la Transformación, Claudia Sheinbaum Pardo, quien estará en Chiapas este jueves como parte de su gira “La Esperanza nos Une”. “La visita de Claudia Sheinbaum a Chiapas refleja su compromiso de construir un México más fuerte, unido y próspero para todos sus habitantes, a lo que nos vamos a sumar con trabajo y dedicación por el bien del pueblo y de la 4ta transforma -

ción”, dijo. Destacó la unidad que se ha reflejado por parte de los integrantes del Movimiento de Regeneración Nacional en favor de Sheinbaum Pardo, siempre con el objetivo de velar por los intereses del pueblo, siguiendo los ejemplos del presidente de la república, Andrés Manuel López Obrador y del Gobernador del Estado, Rutilio Escandón Cadenas.
Brito Mazariegos hizo extensa la invitación a la población para acudir al evento que se estará realizando este jueves, en punto de las 10 de la mañana en el foro Chiapas de la ciudad capital.
SIN AVANCES
Aún no caen los autores intelectuales del asesinato de Mario Gómez
RUBÉN PÉREZ-EL SIE7E FOTO:RUBÉN PÉREZ
Tuxtla.- Para Nancy y Henry Gómez Sánchez es lamentable que, a cinco años del asesinato de su hermano, el periodista Mario Leonel Gómez Sánchez, sólo haya tres procesados por ese hecho, pero “ningún asesino intelectual”.
Comentaron que hasta el momento la Fiscalía General del Estado (FGE) no ha presentado ni un solo avance sobre quién o quiénes ordenaron el crimen del excorresponsal en Yajalón del periódico El Heraldo de Chiapas y otros medios informativos de circulación estatal.
El pasado martes, recordaron que acudieron a la Sala 03 de Justicia de San Cristóbal de Las Casas en donde estuvieron tres magistrados, quienes presidieron la audiencia, se desahogaron algunos alegatos, por la apelación interpuesta por los abogados de los sentenciados.

Dentro de tres días, agregó por su lado Nancy, habrá una resolución de la apelación, “es decir, probablemente este viernes darán el veredicto final, si se ratifica o no la sentencia, pero eso dependería de los magistrados; aunque consideramos que deben ratificar esas sentencias y, además, considerar la labor periodística de Mario”. Además, reiteró que en la recomendación que emitió en su momento la Comisión
SECRETARIO DE HACIENDA
COMUNICADO-EL SIE7E FOTO:CORTESÍA
Tapachula.- El secretario de Hacienda, Javier Jiménez Jiménez, asistió en representación del gobernador Rutilio Escandón Cadenas al Segundo Informe de Gobierno que rindió la presidenta municipal de Tapachula, Rosa Irene Urbina Castañeda.
“Cuando hay un trabajo serio de un funcionario municipal los resultados están a la vista, y siguiendo el ejemplo del gobernador del estado, debemos trabajar con disciplina, tenacidad y compromiso por el pueblo”, afirmó Javier Jiménez Jiménez.
Ante las y los asistentes, señaló que México y Chiapas se están transformando con pasos seguros, hacia la consolidación de este movimiento en donde todas y todos somos partícipes, porque se toma en cuenta a la sociedad y las decisiones se asumen pensando en el interés colectivo.
El secretario de Hacienda aseguró que ahora el recurso público alcanza para más infraestructura hospitalaria, de caminos, obras públicas, y hoy el presupuesto llega en tiem -

po y forma a los 125 municipios, a fin de que se realicen y generen las actividades económicas necesarias. “Hay acciones y gestiones gubernamentales de verdad”, sostuvo.
Javier Jiménez reconoció el trabajo municipal en Tapachula, y reiteró el acompañamiento del Gobierno Estatal para seguir avanzando en todos los rubros.
Estatal de Derechos Humanos (CEDH) se establece que debe de darse la debida atención e integración de la carpeta de investigación, “pero hasta ahorita no hay una carpeta ni documento en donde haya una pesquisa que nos diga quiénes son los autores intelectuales o hasta dónde va ese proceso”.
Para la FGE, comentó que es algo incómodo solicitar los informes relacionados a esta última petición, lo que ha demorado aún más el proceso.
Mario Gómez fue asesinado a balazos a las afueras de su casa en su natal Yajalón, el 21 de septiembre de 2018, por parte de un sicario que se desplazaba en motocicleta con otro sujeto. Antes de su muerte, el periodista ya había recibido amenazas.
PROTESTA
Maestros exigen pago de sueldos y basificaciones
RUBÉN PÉREZ-EL SIE7E FOTO:RUBÉN PÉREZ
Tuxtla.- Personal docente de la Escuela Secundaria del Estado número 3 se manifestó este miércoles frente a Palacio de Gobierno, para exigir el pago de los sueldos de quienes cubrieron grupos de nueva creación, “pero desde el 2016 no hemos recibido ni un centavo”.

Sergio Solís Chacón, en representación de los 20 afectados, lamentó que a pesar de que Tuxtla sea capital de Chiapas aún tengan carencias, “no es un movimiento por gusto, sino por necesidad, porque buscamos que los niños reciban una educación de calidad”.
Comentó que son cinco años de adeudos, es decir de 2016 a 2021, además, refirió que, desde esa fecha, han solicitado la basificación de tres grupos, el primero, segundo y tercero B, “ya se hizo un trabajo, lo hicimos con gusto, pero no nos pagan”.
Aclaró que el argumento que les ha dado la autoridad es que no cuentan con un presupuesto para hacerles esos pagos, sin embargo, criticó que haya funcionarios de gobierno en “plena campaña política” con el uso de recursos públicos.
Mencionó que lo único que buscan es que
haya un México con certidumbre, lo que dependerá, consideró, de la educación que se le brinde a los niños y niñas.
De hecho, puntualizó que tienen otro problema: exceso de matrículas, es decir el primer grado con hasta 50 estudiantes, segundo con igual número, mientras que hay cerca de 20 que no se pudieron inscribir.
“Necesitamos, de manera urgente, que se abran el primero y segundo B, porque es imposible trabajar con 50 alumnos, es demasiado, y por eso, por tercera vez, nos manifestamos, y nos quedaremos acá, de manera definitiva, hasta que nos atiendan”, aseveró.
Recordó que, durante todo este tiempo, han sostenido una serie de reuniones con autoridades educativas, sindicato, pero nadie les ha dado una respuesta positiva a sus demandas.
21 DE SEPTIEMBRE DE 2023 SIE7E DE CHIAPAS 4 4 ESTATAL
DIPUTADO FEDERAL
Asiste Javier Jiménez al segundo Informe de Gobierno en Tapachula
AGUILAR CASTILLEJOS
COMUNICADO-EL SIE7E FOTO:CORTESÍA
Tuxtla.- El delegado de Programas para el Bienestar, José Antonio Aguilar Castillejos; en compañía del coordinador estatal del programa de Becas Benito Juárez, Ernesto Gómez Panana; anunció de manera oficial el inicio de un nuevo período de incorporaciones al sistema de becas que el Gobierno Federal otorga.
En este nuevo período de incorporaciones se podrán registrar todas y todos los alumnos inscritos en instituciones educativas catalogadas como susceptibles y prioritarias, a través del sitio electrónico: buscador.becasbenitojuarez.gob. mx.escuelas, en este sitio las y los aspirantes deberán ingresar la Clave del Centro de Trabajo de la institución educativa a la que pertenecen, detalló Gómez Panana. El Gobierno de México mantendrá activo este período de registro hasta el 23 de septiembre del año en curso, creando nuevas oportunidades educativas que no solo brinda un apoyo financiero, sino también la posibilidad de un futuro brillante y equitativo para las y los estudian -
tes chiapanecos.
Aguilar Castillejos detalló que actualmente en Chiapas más de 700 mil familias reciben el apoyo de becas Benito Juárez, representando el padrón más grande de todo el país; además, con esta nueva etapa de incorporaciones se estima que el padrón aumente a 850 mil familias beneficiarias.
El sistema de Becas Benito Juárez otorga apoyos económicos a la población estudiantil de los tres niveles educativos como educación básica, media superior y superior, para sumar a la permanencia y conclusión del nivel educativo en el que el o la alumna se encuentre inscrito.
PROTESTA
Alumnos de secundaria
denuncian falta salones y maestros
CARLOS LUNA -EL SIE7E FOTO:CARLOS LUNA
Tuxtla.- Decenas de padres de familia, maestros y alumnos de la Escuela Secundaria del Estado Número 3, localizada en la Colonia Jardines del Norte, realizaron una protesta en el centro de Tuxtla Gutiérrez para exigir, la ampliación de los grupos y dotar de infraestructura y docentes a esta institución. Indicaron que, han acudido ante las autoridades en por lo menos 3 ocasiones, sin que les den atención a este tema. Señalaron que, la Secretaría de Educación del Estado no ha oficializado, desde hace 5 años, tres grupos de la Escuela lo que motivó a que padres, profesores y alumnos a manifestarse. El docente de matemáticas y fundador de la secundaria Horacio Nucamendi Nucamendi, dijo que, la institución se creo para dar la posibilidad de estudios a chicos de la calle” en una zona de cinturón de pobreza en Tuxtla Gutiérrez; la escuela creció hasta tener un segundo grupo, el cual tuvo cobertura por un grupo de profesores sin base, pero con todo el perfil.

“Dijo que, aunque todos los documentos fueron entregados a la Secretaria, no se oficializó y al no hacerlo, el grupo de maestros que subían solamente
SIN SOLUCIÓN A DEMANDAS
Continúa bloqueo en Tuxtla por alumnos del ISSSECH

Tuxtla.- Los alumnos del Instituto Superior de Estudios de Enfermería del Estado de Chiapas (ISEEECH), en el Bulevar Belisario Domínguez, continúan bloqueando el Bulevar Belisario Domínguez, a la altura de la entrada al Fraccionamiento Laureles, ante la falta de solución a sus demandas.
Los estudiantes, señalaron que no existe hasta el momento no han tenido un acercamiento con el director Celso Antonio Hernández Prieto. Exponen la falta de gestión para obtener espacios en campos clínicos, hospitales y clínicas, para realizar su servicio y prácticas profesionales.
Indican que, esto se debe a una mala gestión de la dirección. Lamentaron que, en una actitud de choque, este martes por la tarde el director se paseó por la protesta sin tomar en cuestión el llamado de los manifestantes al díalogo y solución del conflicto.
Ante ello, sentenciaron que, continuarán con este bloqueo y protesta
hasta las últimas consecuencias. Hasta el cierre en la edición de esta información, la vialidad permanecía cerrada.
El reporte de los jóvenes que permanecen en el plantón, dieron a conocer que, no se ha tenido un acercamiento con el director o alguna propuesta de las autoridades educativas.
Este bloqueo, ha generado el encono de la ciudadanía que se ha pronunciado en redes sociales por la solución de este conflicto.
a cubrir esas horas, por problema de economía y de incertidumbre tuvieron que abandonar la escuela”, expresó. Esto generó que los grupos de primero y tercero B dejarán de atenderse, y que los docentes de base den clases a grupos altamente cargados afectando su calidad educativa.
El docente agregó que, “Nos han abierto mesa de diálogo pero no hemos visto absolutamente nada de solución, no hay respuesta, en la actualidad los maestros de base, que también nos adeudan los grupos b, seguimos atendiendo como corresponde a la matrícula, dando clases a 50 alumnos por grupo y dejando a por lo menos 20 alumnos fuera de la escuela”. La demanda principal es la ampliación de los grupos, y se asignen docentes sin importar que para ellos se realicen evaluaciones a docentes. Y que a los maestros que están trabajando con los grupos B se les paguen los años de trabajo.
Maestros se movilizarán por la inseguridad en Chiapas
CARLOS LUNA
-EL SIE7E FOTO:CARLOS LUNA
Tuxtla.- El Secretario Ejecutivo de la Asamblea Estatal Democrática (AED) a de la Sección 40, Armando Falconi Borráz del Sindicato de Trabajadores de la Educación (SNTE) comentó en entrevista que el magisterio chiapaneco se podría volver a movilizar en próximos días para exigir seguridad.


Debido a la ola de violencia e inseguridad que se ha presentado recientemente en la entidad, la cual pone en riesgo a la población, a los alumnos, a sus compañeros maestros y a los padres de familia.
Agregó que: “Los compañeros maestros de educación indígena aprovecharon ayer para hacer un bloque por la cuestión de que no ha habido plazas bases para los compañeros maestros y tampoco ha habido pagos y ahí aprovecharon para denunciar esta ola de violencia que se vive en el estado”, sostuvo.
Señaló que, hasta ahora no ha habido ni siquiera un pronunciamiento por parte de la Secretaria de Educación, Rosa Aidé Domínguez
Ochoa, a quien señaló de estar en una actitud pasiva y no decir nada con respecto a la ola de violencia que se vive en el estado.
Asimismo pidió, a los elementos del ejército y de la Guardia Nacional hacerle frente a la delincuencia en la parte de la Sierra Madre de Chiapas, en municipios como Motozintla, Siltepec, Bella Vista, Amatenango de la Frontera y toda esa parte de la región de Frontera Comalapa donde se ha recrudecido la violencia.
“Estamos abrazando la Lucha de todos los compañeros que han estado movilizándose ya sean la iglesia, organizaciones populares ante esta ola de violencia, que pone en riesgo a los maestros que transitan diariamente a sus comunidades”, remarcó.
21 DE SEPTIEMBRE DE 2023 · SIE7E DE CHIAPAS 5 ESTATAL
CARLOS LUNA -EL SIE7E FOTO:INTERNET
SNTE
Anuncian la apertura del sistema para incorporación a las Becas Benito Juárez
ESTAR CONSCIEN7E
Ser responsables, la clave para ser felices

ALEJANDRA OROZCO-EL SIE7E FOTO:CORTESÍA
Tuxtla.- De nueva cuenta, recibimos en esta casa editorial a Lakshmi Shakti, quien felicitó a nuestro director Gastón Müller por su reciente cumpleaños… y es que curiosamente, ambos son virgo, para quienes creen en esto de los astros, que si bien tienen una ligera connotación con nosotros, ella considera que no mueven nuestras vidas, de lo contrario, seríamos como hojas sopladas por el viento, a veces dicen, por ejemplo, que “virgo no se lleva con cáncer”, y si haces caso, a lo mejor te estarías limitando de ciertas relaciones.

“Por ejemplo, está comprobado científicamente que la luna mueve mareas, que en luna llena hay mejores apareamientos y cosechas, esa energía está comprobada, pero no podemos regirnos con todo lo que los astros dicen, tú tienes que tomar tu poder y ser responsable, no puedes responsabilizar a Júpiter porque te fue mal o tu día no fue brillante, no puedes poner todo tu poder en los astros o dioses que creas, tú tienes tu poder y tu responsabilidad de ti y de tu vida”, señaló.
Sin embargo, dijo que nos da miedo hacernos cargo al 100 por ciento, a fallar, a no poder ni ser suficientes, por lo tanto nuestra responsabilidad se la aventamos a los astros, a Dios, al gobierno, a la pareja, a los padres, no me hago responsable ni me responsabilizo por ti, y es que lo cierto es, que los planetas, la naturaleza, el dios en el que creas tienen influencia, energía y hay que
tomarla, pero ¿qué tanto le cedes tu poder a esa energía?
“Por ejemplo, cuando decimos el famoso ‘si Dios quiere’… ¿cuándo vas a saber si quiere o no? es si tú quieres, anda y ve, yo creo que Dios te ama y te dio el libre albedrío, la vida y este planeta, abre tu camino, no dejarle todos tus problemas, o decir ‘que el universo conspire a tu favor’, no estoy desacreditando a nadie, pero si tú no tomas tu poder y responsabilidad en tu vida, de tus acciones, pensamientos y movimientos, seguirás en ese infierno”, dijo. Por cierto, la puedes encontrar como Lakshmi Shakti en todas las redes sociales, si bien ella realiza la lectura de tarot o constelaciones, te dice que no le des todo tu poder, ella maneja el tarot de Marsella que es terapéutico, te da herramientas que no has visto, te ayuda para que tú, no los dioses ni nadie más,
arregles tu problema, tienes que ser responsable.
“Otra cosa es que idealizamos mucho, nosotros no somos responsables por las proyecciones del pasado, hace años atrás me di cuenta que no sabía ahorrar y que yo decía: mis papás no me enseñaron, responsabilicé a mis papás en el pasado, pero yo me tengo que hacer responsable de mi economía, crecí y dejé de ser esa niña, ¿y luego? ¿Por la culpa de mis padres no ahorro? Es falta de responsabilidad y proyectar el pasado, no ser responsable, hay gente a la que sus papás le enseñaron a aguantar golpes, obligaciones, es muy duro porque ya estás hablando de tu integridad como persona, como ser humano, o soy borracho porque es lo que me enseñaron, el pasado no lo puedes cambiar, pero sí lo que siente tu corazón en este momento
presente”, dijo.
La idea es sanar tu dolor, ya sea con los demás o tú mismo en tu niñez y juventud, qué esperas para hacerte cargo de ti al 100 por ciento, todo va de la mano, cómo cambiar esos patrones de conducta que tengo en el presente y arrastro del pasado, para esto primero está la paz, vale la pena ver los primeros programas donde se habló de esto, luego viene el perdón, de nuestros errores, de lo que no sabíamos hacer, quizá solo sabíamos una forma, luego tenerte compasión, dejar que el amor fluya en ti, todos tenemos derecho a vivir bien, pero no todos lo toman, cada experiencia es diferente, compasión para los que no saben, para los que lo ven lejano.
“Y es que el mundo, la vida es un campo tan grande, tan abierto, que sí podemos comenzar a trabajar en nosotros, en un proyecto, no es fácil pero tampoco imposible, si no has pasado todos estos procesos, ¿cómo vas a hacerlo? Con odio, rencor, proyecciones, drama, siendo víctima de tu pasado, de tus circunstancias, tener poder es la virtud de la responsabilidad, tener responsabilidad es un gran poder y no todos lo toman, yo no fui responsable en su momento y eso me llevó a sentir mucho dolor, cuando más responsable, más poderoso eres”, señaló.
En resumen, lo primero es entender que eres el único responsable de tu vida, de tus acciones, vete al espejo, mírate a los ojos y di: soy responsable de mi, de mi vida, de mis acciones, y hoy voy a actuar responsablemente.

21 DE SEPTIEMBRE DE 2023 SIE7E DE CHIAPAS 6 ESTATAL
“LA ESPERANZA NOS UNE”
COMUNICADO-EL SIE7E FOTO:CORTESÍA
Tuxtla.- Claudia Sheinbaum continuará con sus trabajos como Coordinadora Nacional de Defensa de la Cuarta Transformación en Tuxtla Gutiérrez, Chiapas, este jueves 21 de septiembre, en donde encabezará el encuentro ‘’La Esperanza Nos Une Chiapas’’ en el Foro Chiapas a las 11:00 horas.

La visita de Claudia Sheinbaum a este estado del sureste mexicano se da en el marco de los trabajos
a favor de la unidad de la 4T, con el objetivo de dar seguimiento a la convocatoria abierta para que sean cada vez más las personas que se sumen a la construcción del segundo piso de la Transformación, sin importar su género, creencia religiosa e incluso militancia partidista. La llegada de Sheinbaum Pardo al estado de Chiapas marca el inicio de un intenso fin de semana de actividades en defensa de la Cuarta Transformación, en las cuales estará acompañada del presidente nacional de Morena, Mario Delgado.
LLAVEN ABARCA
COMUNICADO-EL SIE7E FOTO:CORTESÍA
Tuxtla.- En el marco de la comparecencia del secretario de Hacienda y Crédito Público, Rogelio Ramírez de la O, el diputado federal Jorge Llaven Abarca destacó que hoy el pueblo de México cuenta con finanzas sanas gracias a la buena administración del recurso público, lo que ha permitido mantener una estabilidad económica sin endeudamientos. En ese sentido, Llaven Abarca expresó que uno de los principales ejes de la Cuarta Transformación que encabeza el presidente Andrés Manuel López Obrador ha sido la óptima racionalidad en el uso de los recursos internos a favor de los que

menos tienen.
“Escuchamos la comparecencia del secretario de Hacienda y Crédito Público, Rogelio Ramírez de la O, hoy el pueblo de México cuenta con finanzas sanas y sólidas gracias a la buena administración del recurso público con disciplina fiscal y con la política de austeridad impulsada desde el inicio de esta administración”, declaró.
Por último, Llaven Abarca aseveró que el Grupo Parlamentario del Partido Verde Ecologista de México (PVEM) continuará levantando la voz para defender y aprobar los proyectos que atienden las principales necesidades del pueblo de México y Chiapas, siempre privilegiando a los que menos tienen.
MORENA
COMUNICADO-EL SIE7E FOTO:CORTESÍA
Tuxtla.- El presidente del Comité Ejecutivo Estatal del Movimiento Regeneración Nacional (Morena), Carlos Molina, compartió que la militancia guinda y simpatizantes de Chiapas mantienen su compromiso en unidad y movilización, listos para sumarse en esta nueva etapa del proyecto.

En breve entrevista, Molina externó que en el estado se trabaja de forma constante en la unidad, siempre informando y promoviendo los logros que a través de este trabajo interno se ha logrado, una muestra de ello es como se ha afianzado la entrega de los programas sociales “gracias al trabajo y compromiso del gobernador Rutilio Escandón y la Federación, en conjunto, hoy Chiapas ha logrado ampliar su padrón de personas adultas mayores y así procurar una vejez con dignidad”. En ese mismo contexto, el líder estatal de Morena precisó que en esta nueva etapa se abraza y acuerpa el proyecto de continuidad para consolidar la Cuarta Transformación del país, donde el mayor
objetivo es seguir haciendo justicia social a quienes menos tienen. “Hoy en Chiapas caminamos con nuestra coordinadora nacional de los Comités en Defensa de la Cuarta Transformación, Claudia Sheinbaum; la unidad es nuestra mayor ventaja y nuestro proyecto de nación está más vivo que nunca”, concluyó.
CONFLICTO
Retienen a supervisor y cinco maestros en Tzimol
VANESA RODRIGUEZ-EL SIE7E
FOTO:VANESA RODRIGUEZ
SCLC.- Cinco maestros y un supervisor fueron retenidos la mañana de este miércoles en las instalaciones de la escuela Secundaria del Estado “Emiliano Zapata”, en la localidad San Vicente La Mesilla, en Tzimol, luego de que intentaron instalarse, y dejar fuera a 11 docentes interinos quienes fueron los fundadores de esa institución. De acuerdo a las versiones de los padres de familia, los 11 maestros interinos, daban clases a un aproximado de 200 alumnos en salones de madera desde hace 7 años, pero con el esfuerzo de padres, lograron la construcción de varias aulas y baños para una mejor comodidad de los alumnos.

Tras lograr construir una escuela digna, los 11 maestros que daban clases fueron dados de baja, y en su lugar, la Secretaría de Educación, envió a 5 maestros, quienes son insuficientes para poder cubrir a todos los grupos.
Narran que desde el inicio del ciclo escolar 2023 - 2024, los alumnos
que alberga esta institución, que comprenden un aproximado de 7 localidades, no han recibido clases, por los padres de familia han dado a conocer su inconformidad y piden que se reincorporen los maestros faltantes.
Lamentablemente tras no tener una respuesta positiva por autoridades educativas, los padres de familia decidieron retener a los maestros enviados y al supervisor, con el fin de ejercer presión y que se les dé solución a sus demandas.
21 DE SEPTIEMBRE DE 2023 · SIE7E DE CHIAPAS 7 ESTATAL
Chiapas reafirma su compromiso en unidad y movilización
Hoy el Gobierno encabeza finanzas sanas y sin endeudamientos
Hoy Claudia Sheinbaum visita Tuxtla para continuar con la defensa de la 4T
Rutilio Escandón inaugura construcción de Unidad Deportiva en Venustiano Carranza

COMUNICADO-EL SIE7E FOTO:CORTESÍA
Tuxtla.- En su visita al municipio de Venustiano Carranza, el gobernador Rutilio Escandón Cadenas inauguró la construcción de la Unidad Deportiva, donde subrayó que con este tipo de obras su gobierno abona a la modernización de más espacios de sano esparcimiento que contribuyen a que las familias cuenten con instalaciones dignas, adecuadas, seguras y funcionales para llevar actividad física y de convivencia familiar.

El mandatario estatal celebró que, gracias al ejercicio transparente de los recursos, en Chiapas se ha logrado resarcir los rezagos y cumplir con añejas demandas, muestra de ello es esta infraestructura deportiva, la cual estuvo en malas condiciones por años, y ahora podrá brindar bienestar a las presentes y futuras generaciones. Indicó que el deporte es muy importante porque fortalece el índice de desarrollo humano, facilita el proceso de enseñanza-aprendizaje y es un factor clave para estar en óptimas condiciones de salud. “Si hacemos deporte, estamos despiertos mental y físicamente para aprender mejor y con más eficiencia, porque el deporte motiva y despierta todos los sentidos”, expresó al convocar al pueblo de Carranza a cuidar y gozar de este espacio, el cual cuenta con equipos de ejercitación, juegos infantiles y de reanimación, así como canchas de futbol, de basquetbol,
entre otras áreas funcionales y seguras para eventos deportivos y sociales.
En ese sentido, Escandón Cadenas destacó que, derivado del impulso de importantes obras y acciones que el gobierno de la Cuarta Transformación ha materializado a lo largo de estos cinco años, en México y Chiapas ha disminuido la pobreza y las desigualdades, lo que equivale a que cada día haya más personas con mejores posibilidades y oportunidades de desarrollo.
Este logro, señaló, se deriva de la visión del presidente Andrés Manuel López Obrador, quien trabaja primero por los pobres para que todas y todos puedan alcanzar la plenitud, igualdad, independencia y libertad; por eso, “todos los días trabajamos con responsabilidad, honestidad y compromiso, haciendo a un lado el cáncer de la corrupción, para que el recurso alcance y se pueda dar satisfacción al pueblo. Tengan confianza, no les vamos a fallar”, apuntó.
Al informar que esta región también contará con una Clínica para la Atención de Parto Humanizado y se continuará con la rehabilitación de escuelas y de otros espacios, el gobernador refrendó su compromiso de seguir trabajando e invirtiendo hasta donde humanamente sea posible para que el pueblo alcance bienestar y pueda caminar con dignidad. Todas y todos, dijo, tienen derecho de gozar de sus recursos y de la riqueza pública que contiene el país.
En tanto, el secretario de Obras Públicas, Ángel Torres Culebro, mencionó que, con la entrega de la Unidad Deportiva, en la que se invirtió más de 45.7 millones de pesos, se brinda a las familias espacios de convivencia sana, en donde niñas, niños y jóvenes se acerquen al deporte y se alejen de los malos hábitos. Aseguró que, gracias al liderazgo del Gobernador, se trabaja con responsabilidad y el presupuesto se utiliza de manera correcta.
Mientras que, la directora del Sistema DIF, Deliamaría González Flandez, reconoció el compromiso del Gobierno de Chiapas por construir comunidades con mayores oportunidades de empleo, bienestar y progreso; al tiempo de señalar que con el fortalecimiento de la infraestructura social y deportiva también se abona a la salud, tranquilidad y el desarrollo integral de la niñez y juventud chiapaneca. En nombre de las y los beneficiados, Manuel Segundo Zavaleta agradeció la construc-
ción de esta unidad deportiva y reconoció el respaldo que el gobernador Rutilio Escandón mantiene con su pueblo, al materializar los sueños de la gente, mediante el impulso de importantes obras de beneficio social, las cuales han cambiado el rostro de Venustiano Carranza. “En Chiapas, los discursos quedaron atrás, hoy las obras hablan por sí solas”. En ese marco, Escandón Cadenas hizo entrega de Constancias de Capacitación del Curso “Primeros Auxilios”, instruido por el Instituto de Capacitación y Vinculación Tecnológica del Estado de Chiapas (Icatech), con el propósito de que la población aprenda e identifique los principios básicos de primeros auxilios, así como reconocer los signos vitales y de reanimación, e identificar de manera inmediata las lesiones musculo-esqueléticos, mordeduras, picaduras e infartos.
El mandatario señaló que la capacitación ha representado una alternativa eficaz para que la gente cuente con los conoci-
mientos suficientes y facilitar el autoempleo. A su vez, anunció que, a través del Sistema DIF se fortalecerá a Carranza con la instalación de una Clínica de Atención a Personas con Autismo.
A su vez, la directora general del Icatech, Fabiola Lizbeth Astudillo Reyes, refirió que el Curso de Primeros Auxilios tiene el objetivo de saber cómo reaccionar en caso de algún accidente. Agregó que en Venustiano Carranza se ha capacitado a 6 mil 539 personas en distintos rubros, y dijo que el lunes arribará la Unidad Móvil de Capacitación. Finalmente, el presidente municipal de Venustiano Carranza, José Luis Avendaño Borraz, agradeció el respaldo del gobernador por este espacio para las y los deportistas de todas las edades, al tiempo de reconocer las diferentes obras que ha impulsado para atender las necesidades de Venustiano Carranza y asegurar que continuará sumado a estos esfuerzos para sacar adelante a este municipio.
21 DE SEPTIEMBRE DE 2023 SIE7E DE CHIAPAS 8 8 ESTATAL
DEMANDA AÑEJA
CUMPLIMIENTO DE
•Indicó que el deporte fortalece el índice de desarrollo humano, facilita el proceso de enseñanza-aprendizaje y es un factor clave para estar en óptimas condiciones de salud
Nacional
Jueves 21 de septiembre de 2023
Desmiente AMLO que el Ejército no entregará el informe completo sobre Ayotzinapa
COMUNICADO · EL SIE7E
CDMX.- En la conferencia de prensa de este miércoles, el presidente Andrés Manuel López Obrador desmintió que el Ejército no haya entregado toda la información sobre el caso Ayotzinapa. En ese contexto, López Obrador compartió que, a la fecha , se ha avanzado en las investigaciones y descartó una ruptura con las familias, porque “no hemos fallado ni vamos a fallar”, subrayó. El mandatario federal descartó los argumentos esgrimidos por el Grupo Interdisciplinario de Expertos Independientes (GIEI) que en su último informe sobre los hechos planteó que tanto el Ejército como la Marina tienen “información vital” para el caso, la cual aún no se ha dado a conocer. A un año y diez días que termine su mandato, el jefe del Ejecutivo se comprometió a resolver el caso.
“Tenemos mucho avance, y una de las cosas que nos va a ayudar mucho a contrarrestar todas estas calumnias va a ser el que vamos a dar a conocer toda la información, todo lo que podamos, que no haya problemas de carácter legal, pero todo. Porque cuando se informa, no pue -
de haber inventos, es muy difícil distorsionar las cosas, cuando hay información no puede haber fácilmente manipulación. Se le interrogó si hay un riesgo de ruptura con los padres, a lo que el presidente Andrés Manuel López Obrador contestó:

“No hay motivo de rompimiento, no hemos fallado, ni vamos
a fallar, e independientemente de lo que puedan decir en este caso los padres, que tienen todo el derecho de manifestarse, porque es mucho el dolor por la ausencia de sus hijos, y eso es entendible, es muy humano; pero independientemente de eso y de lo que puedan decir, y eso me importa muchísimo menos,
los medios de manipulación, lo importante aquí es tener la conciencia tranquila”. El jefe del Ejecutivo federal refirió que el caso ha sido manejado por los conservadores y reaccionarios para atacar a su administración, a lo que, aseguró, se han sumado grupos de “seudodefensores de de -
rechos humanos, aliados con organismos internacionales de derechos humanos, incluso de la ONU, de la OEA, que se han dedicado a medrar con el dolor de la gente, porque ellos viven muy bien, ganan muchísimo dinero, ganan en dólares, y tienen un pensamiento también muy conservador, muy reaccionario”.
Claudia Sheinbaum continuará su gira por Chiapas, Sonora, Sinaloa y Oaxaca

EFE - EL SIE7E
CDMX.- La Coordinadora Nacional de los Comités de Defensa de la Cuarta Transformación, Claudia Sheinbaum Pardo, informó que el día jueves 21 de septiembre estará en Tuxtla Gutiérrez, Chiapas; viernes 22, en Hermosillo, Sonora; sábado 23, Culiacán, Sinaloa; y domingo 24, en Oaxaca, Oaxaca. Así lo dio a conocer Sheinbaum Pardo en sus redes sociales, donde explicó que el objetivo es acercarse a los militantes y simpatizantes del Movimiento Regeneración Nacional (Morena), así como para instalar los Comités de Defensa de la Cuarta Transformación.
Cabe recordar que su primer Comité de Defensa de la Cuarta Transformación lo realizó este fin de
semana en Morelia, Michoacán, donde se llevó a cabo la firma del primer Acuerdo de Unidad para la Transformación con personalidades de distintos ámbitos y profesiones. Durante el evento se sumaron académicos, entre ellos la primera rectora de la Universidad Michoacana de San Nicolás Hidalgo, empresarios y líderes del Consejo Coordinador Empresarial, indígenas, artesanas, artistas, presidentes municipales y representantes de partidos que se cambiaron a Morena. En este sentido, la exjefa de Gobierno de la Ciudad de México, Claudia Sheinbaum, invitó a sus seguidores y simpatizantes a estar atentos a sus redes sociales para conocer más información, ya que también comparte enlaces en donde envía el mensaje de unidad a los Comités.
www.sie7edechiapas.com
www.sie7edechiapas.com
Se arma pelea física y verbal en el Congreso por el Paquete Económico 2024
- EL SIE7E
Ciudad de México.- Congresistas mexicanas armaron este miércoles una escaramuza verbal y física en medio de la discusión del paquete económico 2024, el cual incluye el gasto público para el Gobierno mexicano.
El rifirrafe se dio luego de que el titular de la Secretaría de Hacienda y Crédito Público (SHCP), Rogelio Ramírez de la O, compareciera ante la Cámara Baja del Congreso mexicano por ley y presentara los lineamientos del presupuesto para México en 2024.

El descontrol comenzó cuando legisladores de la oposición levantaron mantas para descalificar la actuación en la política económica del actual Gobierno mexicano, encabezado por el presidente Andrés
Manuel López Obrador, lo que de inmediato provocó que la reacción de las diputadas del Movimiento Regeneración Nacional (Morena), quienes se colocaron máscaras de los expresidentes de México.
En este punto, comenzaron los empujones y manotazos cuando legisladoras de oposición y del oficialismo se acercaron a sus escaños para tratar de bajar las mantas y tapar las máscaras.

En este acercamiento, la diputada trans de Morena, María Clemente, lanzó insultos a las diputadas de la oposición calificándolas de “perras”.
Después, Clemente aseguró que los insultos no iban dirigi -
dos a legisladoras, al tiempo que sostuvo que las diputadas del conservador Partido Acción Nacional (PAN) “se colocaron solas el saco”. Abundó que, por el contrario, ella sí se asumía como “una perra” del presidente López Obrador y enfatizó: “estoy aquí para defender a la cuarta transformación”, movimiento del mandatario.
En contraste, la diputada de oposición Melissa Vargas dijo que por “prudencia” no contestó aunque también se asumió en la misma condición al afirmar: “somos perras (…) pero para defender a México del endeudamiento histórico que les quieren dejar a las siguientes generaciones”.
“Sí María Clemente, somos feroces y seguiremos (…) para defender a México de Morena”, concluyó.
De acuerdo con el paquete económico 2024 el déficit presupuestario de México para el siguiente año será el más alto desde que se tiene registro, con un gasto público superior a los 9 billones de pesos (unos 494.000 millones de euros) e ingresos por casi 7 billones de pesos (384.000 millones de euros).
El Congreso mexicano tiene hasta finales de octubre para aprobar la parte relacionada a los ingresos en el paquete económico 2024, mientras que tiene hasta el 15 de noviembre para aprobar el gasto público del siguiente año en el que habrá elecciones presidenciales.
EXJEFE DE LA POLICÍA DE LA CDMX
Omar García Harfuch anuncia que buscará gobernar la Ciudad de México
EFE - EL SIE7E
Ciudad de México.- El exjefe de policía de la Ciudad de México, Omar García Harfuch, conocido por sobrevivir a un atentado del crimen, anunció este miércoles que buscará la candidatura para ser el jefe de Gobierno capitalino por parte del oficialista Movimiento de Regeneración Nacional (Morena).
“(Quiero) comunicar a todas y todos ustedes, y a la sociedad en general, la decisión que he tomado de participar en el proceso interno de Morena para la selección de coordinador de defensa de la transformación en la Ciudad de México”, expresó en una conferencia de prensa.
El exfuncionario dijo que quiere participar “y dar continuidad a la construcción de una ciudad en paz y segura, donde el desarrollo económico y social sea para todas y todos”.
Destacó que durante su gestión al frente de la policía (2019-2023) escuchó las necesidades “más urgentes” de la población. Y afirmó apoyar el “proyecto humanista” del presidente de México, Andrés Manuel López Obrador. “Compartimos el ideal de que debemos luchar por erradicar la pobreza, la corrupción y la desigualdad”, detalló. El anuncio ocurre un día después de que Morena publicó las convocatorias para quienes aspiren a las candidaturas a los 9 gobier -
nos estatales que estarán en juego en las elecciones del 2 de junio de 2024. El registro de aspirantes se realizará entre el 25 y 26 de septiembre. El pasado 9 de septiembre, García Harfuch presentó su renuncia al jefe de Gobierno capitalino, Martí Batres, y anunció su integración al equipo de Claudia Sheinbaum, próxima candidata de Morena a la presidencia.
Uno de los requerimientos para contender a esta candidatura era no ocupar ningún cargo público o renunciar al puesto 180 días antes de la elección del 2 de junio, es decir, el 5 de diciembre.
Una vez concluido el registro de aspirantes, la Comisión Nacional de Elecciones de Morena presentará un listado al Consejo Estatal de la Ciudad de México para que elija a cuatro perfiles, dos hombres y dos mujeres. Posteriormente Morena
realizará tres encuestas para elegir candidato el próximo 30 de octubre.
EL POLICÍA POPULAR Y POLÉMICO Omar Hamid García Harfuch tiene 41 años de edad. Es egresado de Derecho en la Universidad Continental y es licenciado en Seguridad Pública por la Universidad del Valle de México. A lo largo de su trayectoria ha enfrentado a grupos criminales como el Cártel de Tláhuac, La Unión de Tepito, y el grupo Anti Unión, entre otros. En 2019 fue designado por la entonces jefa de Gobierno, Claudia Sheinbaum, jefe de la policía capitalina.
Como el hecho más famoso, el 26 de junio de 2020 fue víctima de un atentado atribuido a miembros del Cártel Jalisco Nueva Generación (CJNG) en Paseo de la Reforma. El auto donde iba a bordo recibió más de 300 disparos.
El nombre del político ha estado ligado a la desaparición de los 43 estudiantes de Ayotzinapa en septiembre de 2014, pues en ese entonces era encargado de vigilar las vías federales de comunicación, atender accidentes o imponer infracciones vehiculares. Sin embargo, él ha negado su participación en los hechos al argumentar que en los días de la desaparición de los jóvenes estaba en el estado de Michoacán y no en Guerrero, donde ocurrieron los hechos.
21 DE SEPTIEMBRE DE 2023 SIE7E DE CHIAPAS 10
GASTO PÚBLICO
EFE
Padres de estudiantes de Ayotzinapa exigen que no se encubra al Ejército
EFE - EL SIE7E
Ciudad de México.- Los padres de los 43 jóvenes desaparecidos de Ayotzinapa, en el sureño estado mexicano de Guerrero, reclamaron este jueves en una reunión con el presidente Andrés Manuel López Obrador que el Ejército entregue la documentación faltante sobre el caso y que podría ayudar a dar con el paradero de los estudiantes.
“No tenemos una visión ni una sensación positiva de la reunión. El presidente insiste mucho en que ya se dio toda la información, cuando esto es inexacto. Salimos de la reunión con sabor agrio ante un panorama gris”, dijo en entrevista con EFE Vidulfo Rosales, abogado de los padres y madres de los 43 jóvenes desaparecidos en 2014.
El representante legal indicó que el encuentro, que duró algo más de tres horas en el Palacio Nacional, se centró en esta exigencia de que el Ejército entregue documentos faltantes que podrían contribuir al esclarecimiento de muchas de las incógnitas de aquel 26 de septiembre de 2014 y días posteriores.
“Tiene que ver con un conjunto de documentos que el Ejército mexicano tiene en su poder con

motivo de su intervención, que están relacionados, por ejemplo, con que dieron seguimiento a estudiantes, que tenían soldados infiltrados en la escuela normal rural o que intervinieron comunicaciones telefónicas de varios actores”, explicó Vidulfo. Obstrucción y falta de información
Tanto los padres como Rosales recordaron que la existencia de estos documentos faltantes
en lo entregado por el Ejército fue acreditada por el Grupo Interdisciplinario de Expertos Independientes (GIEI) creado por la Comisión Interamericana de Derechos Humanos (CIDH). El grupo recientemente se retiró del país por no poder avanzar en las investigaciones por el obstáculo que implica la falta de colaboración total de las Fuerzas Armadas en la investigación.
ESTADOS
Rosales indicó a EFE que mucha de la información faltante tiene que ver con el paradero de los estudiantes.
Mario César González, padre de César Manuel González, indicó en declaraciones a medios que lo único en lo que están centrándose es en lo que les hace falta “para encontrar a los muchachos”.
Por su parte, Emiliano Navarrete, padre de José Ángel Nava -
rrete, afirmó en declaraciones a medios a la salida de la reunión que “el presidente ha protegido mucho al Ejército desde hace tiempo”.
“Como mexicano, exijo solamente mi derecho de saber dónde están nuestros hijos”, terminó.
Indicaron que el próximo lunes 25 a las 17.00 horas (23.00 GMT) se reunirán, ahora sin el presidente, con la secretaria de Gobernación, Luisa María Alcalde, y con el subsecretario de Derechos Humanos, Población y Migración de la Secretaría de Gobernación, Alejandro Encinas, también en Palacio Nacional.
“Esperemos el lunes algún resultado positivo”, sentenció Rosales.
La reunión ocurrió en vísperas del noveno aniversario de la desaparición de los jóvenes, mientras crece la presión para que López Obrador cumpla con su promesa de aclarar el caso durante su mandato, que termina el 1 de octubre de 2024. La Comisión de la Verdad del Gobierno concluyó el año pasado que el hecho fue un “crimen de Estado” en el que participaron autoridades de todos los niveles, incluyendo las Fuerzas Armadas.
El crimen organizado deja hieleras con restos humanos en Nuevo León
EFE - EL SIE7E
Monterrey.- Grupos criminales mexicanos dejaron este miércoles dos hieleras con restos humanos de dos hombres no identificados, según informaron este miércoles autoridades de Nuevo León, estado del norte de México.
Fuentes policiales allegadas a la investigación establecieron que vecinos del lugar reportaron la presencia de los contenedores, abandonados en el exterior de un negocio de plásticos en el municipio de San Nicolás de los Garza, conurbado a Monterrey, la ciudad más grande del norte de México. En una de las hieleras se localizaron los restos de un hombre, quien vestía un pantalón corto de mezclilla en color azul y una camiseta en color negro.

La segunda víctima también era un hombre que portaba un
pantalón corto en color azul, sin camiseta y con otra probable prenda en color celeste. Los sucesos ocasionaron una
intensa movilización policíaca de agentes municipales, así como de la Agencia Estatal de Investigaciones (AEI) y peritos
encargados de la recolección de evidencias.
Ante los hechos, los oficiales acordonaron el sitio mientras se
realizaban las primeras investigaciones. Las hieleras son de color blanco y en la parte frontal lucía las siglas de un grupo de la delincuencia organizada. En los últimos meses, el nivel de violencia de los grupos de la delincuencia organizada se ha recrudecido en Nuevo León, donde apenas el 16 de septiembre en ese mismo municipio apareció un cuerpo mutilado en la avenida López Mateos. También el pasado 24 de agosto, en el municipio de Salinas Victoria, se realizó el hallazgo de tres cuerpos colgados en un puente peatonal y posteriormente se encontraron tres cabezas en una hielera.
Nuevo León ocupa el décimo lugar en homicidios absolutos en el país, al registrar 842 en los primeros ocho meses de 2023, cuando México en general reportó más de 20.000.
21 DE SEPTIEMBRE DE 2023 SIE7E DE CHIAPAS 11
REUNIÓN





21 DE SEPTIEMBRE DE 2023 SIE7E DE CHIAPAS 12 PUBLICIDAD
Internacional
Jueves 21 de septiembre de 2023
Estados Unidos pedirá a México la extradición de los “chapitos”
EFE - EL SIE7E
Washington.- Estados Unidos solicitará la extradición a México del resto de los hijos del narcotraficante Joaquín “el Chapo” Guzmán, conocidos como los “chapitos”, tras conseguir la de Ovidio Guzmán, reveló este miércoles el fiscal general de Estados Unidos, Merrick Garland.
Garland declaró ante el Comité
Judicial de la Cámara de Representantes que “por supuesto” solicitará la extradición “y la captura de todos” los vástagos del conocido narcotraficante mexicano que actualmente cumple una condena de cadena perpetua en Estados Unidos.
Joaquín “el Chapo” Guzmán, líder del cartel de Sinaloa, tiene cuatro hijos vivos: Ovidio Guzmán, que fue extraditado a EE.UU. el pasado 15 de
septiembre, Iván Archibaldo Guzmán, Jesús Alfredo Guzmán y Joaquín Guzmán. El quinto, que era el primogénito, Édgar Guzmán, fue asesinado en 2008. Los cuatro hijos vivos del narcotraficante son conocidos como los “chapitos” y han sido acusados por Estados Unidos de transportar “sistemáticamente” toneladas de cocaína desde y a través de Sur y Centroamérica
hasta EE.UU.
Ante las preguntas de los congresistas, Garland se negó a calificar la colaboración de México con Estados Unidos para conseguir la extradición de los “chapitos” como buena y se limitó a señalar que la cooperación podría ser mejor.
“Obviamente han trabajado con nosotros con respecto a Ovidio. Su captura por parte de los mexicanos provocó la
muerte de un número significante de marinos mexicanos” reconoció Garland.
“Diría que la cooperación siempre puede ser mejor. Tenemos un grave problema con el fentanilo que llega de México y que es fabricado ahí”, dijo el fiscal general.
“He viajado dos veces (a México) para intentar obtener cooperación”, terminó señalando Garland.
La Guardia Costera de EU decomisa cocaína valorada en 160 mdd
EFE · EL SIE7E
Miami.- La Guardia Costera de Estados Unidos descargó en el puerto de Miami más de 12.100 libras de cocaína (5.490 kilos) decomisada en varias operaciones y valorada en 160 millones de dólares (186 millones de euros), informó este miércoles en un comunicado la institución federal.

La descarga de la droga incautada se llevó a cabo este martes y representa “lo que se puede lograr cuando las agencias de defensa y aplicación de la ley estadounidenses e internacionales trabajan juntas para combatir la entrada de drogas
ilícitas en Estados Unidos, dijo Fernando Pla, teniente de la Guardia Costera del Distrito Siete. Además de la cocaína decomisada, los guardacostas detuvieron a 17 presuntos contrabandistas en las múltiples interceptaciones realizadas en el mar. En estas diversas operaciones participaron también un buque de la Armada Real de los Países Bajos, un buque de la Armada Real Británica, equipos de Aduanas y Protección Fronteriza de EE.UU. y del Grupo de Trabajo del Conjunto Iteragencial Sur. Pla señaló que este trabajo en equipo de coordinación a nivel internacional e interins -
titucional permite “detectar e interceptar a los traficantes de drogas ilegales en alta mar”.

La Fuerza de Tarea Conjunta Interagencial Sur, en Cayo Hueso (Key West), en el extremo sur de Florida, tiene la
tarea de detectar y monitorear el tránsito aéreo y marítimo de drogas ilegales. Una vez que la interceptación se vuelve inminente, comienza la fase de aplicación de la ley de la operación, y el control de
la operación pasa a la Guardia Costera de EE.UU.
Las interdicciones en el Mar Caribe son realizadas por miembros de la Guardia Costera de Estados Unidos bajo la autoridad y control del Séptimo Distrito de la Guardia Costera, con sede en Miami.
Las misiones principales de las embarcaciones de los guardacostas se centran no solo en la interceptación de drogas, sino en “la aplicación de la ley, búsqueda y rescate”, así como el control de la pesca, la interdicción de inmigrantes ilegales, la seguridad nacional y operaciones de defensa y capacitación internacional.
Rusia ataca deliberadamente infraestructuras médicas en Jersón
OMS
EFE - EL SIE7E
Ginebra.- La Organización Mundial de la Salud (OMS) alertó del reciente brote de botulismo en Francia, con 15 casos (uno de ellos mortal), y advirtió que podrían diagnosticarse en los próximos días más infecciones, incluso entre turistas extranjeros, por la afluencia de visitantes con el Mundial de Rugby.
consumidas en un restaurante de Burdeos (según las autoridades sanitarias francesas, el Tchin Tchin Wine Bar) durante la semana del 4 al 10 de septiembre.
El botulismo es una enfermedad grave, con un índice de letalidad de entre el 5 y el 10 por ciento.
EFE - EL SIE7E
Londres.- Rusia ha atacado deliberadamente desde sus posiciones de artillería las infraestructuras médicas de Jersón (sur de Ucrania) tras perder el control de la ciudad el pasado noviembre, según una investigación del Centro para la Resiliencia de la Información (CIR, por sus siglas en inglés).
Al menos siete instalaciones médicas en Jersón fueron objeto de hasta 14 ataques presuntamente ejecutados por cañones rusos entre noviembre de 2022 y mayo de este año, de acuerdo con un informe del CIR al que tuvo acceso la Agencia EFE. “El continuo bombardeo de hospitales, maternidades y centros de rehabilitación podría suponer un riesgo para la sostenibilidad y la operatividad del sector sanitario en la ciudad”, destacan los autores del estudio, que alertan del riesgo de que Rusia repita este patrón de agresiones contra otras localidades de Ucrania.

Según los expertos de esta ONG dedicada a revelar violaciones de derechos humanos y crímenes de guerra a través del examen de imágenes de satélite y redes sociales, Rusia intensificó sus ataques contra infraestructura civil en Jersón tras su liberación, el 11 de noviembre de 2022.
Hasta entonces, bajo dominio ruso, apenas se había registrado un incidente en una instalación médica.
Sin embargo, tras la liberación de Jersón, sufrieron los impactos del fuego de artillería maternidades, centros cardiológicos, centros de rehabilitación y hospitales infantiles.
La mayoría de esas instalaciones fueron atacadas en más de una ocasión, lo que evidenciaría que se trata de un hostigamiento deliberado, a juicio del informe del CIR, que se puede consultar en este enlace: https://www.info-res.org/post/ kherson-after-occupation-mapping-russian-attacks-on-medical-infrastructure.

El primero de esos bombardeos tuvo lugar apenas seis semanas después de que las tropas rusas fueran expulsadas. La maternidad del Hospital Clínico de la Ciudad de Jersón recibió fuego de la artillería rusa el 27 de diciembre de 2022, pese a lo cual no se registraron bajas.
El mes con mayor número de ataques fue el pasado enero, con cinco, mientras que en los pasados diciembre y febrero hubo tres, por dos en marzo y uno en abril.
Entre mayo y julio de este año se apreció un descenso en bombardeos de centros médicos, aunque trabajadores médicos que evacuaban a civiles tras el colapso de la presa de Kajovka sufrieron ataques en junio, y en agosto también se verificaron daños en el citado Hospital Clínico.
El CIR destaca que las acciones rusas guardan gran reminiscen -
cia con las tácticas que empleó este país en las áreas rebeldes de Idleb y Alepo, en Siria, que sufrieron la guerra de desgaste empleada por Rusia para minar a la población civil.
Pese a que los autores del estudio no tuvieron acceso a fragmentos de la munición empleada en Jersón, aseguran que la naturaleza de los ataques apunta a que fueron disparos de cañones, de mayor precisión que los lanzacohetes.
Asimismo, recuerdan que “las impresionantes defensas aéreas” en Kiev no están disponibles en todas las ciudades del país, por lo que podría repetir esta estrategia en otras zonas de Ucrania.
“La única mitigación efectiva (...) es atacar las posiciones de fuego, de tropas y de municiones en el territorio ocupado al sur. Mientras las fuerzas rusas sean capaces de desplegarse en la orilla opuesta del río Dnipro, Jersón seguirá sufriendo”, recoge el informe.
Sin embargo, reconocen que solo uno de los incidentes documentados en su investigación, el bombardeo del edificio sur del Centro de Cardiología Regional el pasado 23 de marzo, proporciona una idea clara de la dirección en que llegó ese ataque. Según los vectores proyectados por los autores, el presunto cañonazo llegó desde una distancia de unos 40 kilómetros, donde Rusia tenía en ese momento posiciones artilleras.
“Dado el periodo de incubación de ocho días y que el restaurante (donde se identificó la fuente de las primeras infecciones) atraía visitantes de otros países durante el Mundial, hay posibilidades de que haya casos adicionales en Francia o fuera del país, cuando los viajeros regresen a casa”, subrayó un comunicado de la OMS.
La agencia sanitaria de Naciones Unidas señaló que la fuente de la infección son sardinas
Los síntomas incluyen signos dolores abdominales, náuseas, vómitos y diarrea, problemas de visión, boca seca acompañada de dificultades para tragar o incluso al hablar, y síntomas neurológicos tales como falta de equilibrio o parálisis muscular.
Es causado por una toxina generada por la bacteria clostridium botulinum, que se desarrolla sobre todo en alimentos mal conservados que no han sido objeto de una esterilización suficiente, como salazones, charcutería o conservas de origen familiar o artesanal.

21 DE SEPTIEMBRE DE 2023 SIE7E DE CHIAPAS 14 INTERNACIONAL
ALERTA ESTUDIO
Advierten de un brote de botulismo en Francia, que podría extenderse entre turistas
Levanta la mano


América

P17 P18 P16 Marcos Domingo Ordóñez, de Tabasco, sería la carta fuerte el Sur para la Federación Mexicana de Charrería
Jueves 21 de septiembre de 2023 www.sie7edechiapas.com Ortiz en busca del playoff Asegurar un lugar en el playoff, no será la única meta del piloto capitalino Diego Ortiz
Deportes
a“nueva”casa
Apuntan
y
Azul
encuentran
Cruz
se
en pláticas con el Estadio de la Ciudad de los Deportes
CHARRERÍA
Un presidente del Sur
ALBERTO CASTREJÓN EL SIE7E
Marcos Domingo Ordóñez Buendía realizó el destape oficial de campaña rumbo a la presidencia de la Federación Mexicana de Charrería, la cita fue el domingo 17 de septiembre en Tuxtla Gutiérrez, Chiapas, en reunión interactiva donde presentó su propuesta y escuchó a todos los asistentes.
El punto de encuentro fue el lienzo de la Unión de Asociaciones de Charros de Tuxtla, donde charros del cinco estados del sureste acudieron al llamado para apoyar este inicio de campaña oficial.

Estuvieron por parte de Chiapas, el PUA Rafael Castillejos Uhlig, así como su mesa directiva con Alfredo Ruiz, Jorge Godínez,
TAEKWONDO BOXEO
múdez Albores, el padre del visitante, Manuel Ordóñez, así como Guillermo Priego entre diferentes personalidades de la tierra del edén. Se concentraron más de 110 presidentes de asociaciones provenientes de Tabasco, Veracruz, Yucatán, Quintana Roo, y Chiapas, esposas de los mismos.
También acudieron al llamado las escaramuzas para formar parte de esta reunión que sirvió para escuchar la propuesta de Marcos Domingo Ordóñez Buendía, así como prensa local. En un inicio Marcos Domingo Ordóñez Buendía mencionó su trayectoria de más de 40 años de experiencia, destacando sus logros deportivos desde los 12 años como Charro Completo, campeón estatal, regional y logrando títulos nacionales.
Un buen aniversario El torneo muy patrio
ALBERTO CASTREJÓN - EL SIE7E
La Academia del Instituto Deportivo Profesional (INDEPROF) de Tae Kwon
Do “Guerreros Olímpicos”, llevó a cabo la celebración de su tercer aniversario de existencia, con Torneo Estatal de Formas (Poomsae), Combate Libre (Kyorugui) y Team Cinco en ambas ramas, que se realizó el pasado domingo en las instalaciones del gimnasio de usos múltiples del “Panchón Contreras” del Imss.

Certamen que reunió a un promedio de 200 competidores de las categorías infantil, juvenil y adultos, provenientes de 20 escuelas de los diferentes municipios de la geografía chiapaneca, que buscaron desde el inicio de las diferentes competencias los primeros lugares del certamen que ofreció un buen espectáculo arte marcialista.
Cabe destacar que los ganadores de los primeros lugares de cada categoría, se le entregó una medalla alusiva al evento, así mismo premio a las tres escuelas ganadoras del torneo, entre -
gándoles trofeos en forma de copa, el primer lugar correspondió a la escuela “Team Calzada”, seguida de Panamericano “Leones” y de INDEPROF Central. En entrevista con el Profr. Juan Carlos de la Cruz Zorrilla, Presidente Nacional del Instituto Deportivo Profesional (INDEPROF) de Tae Kwon Do, destacó que fue una excelente organización el desarrollo del tercer aniversario de INDEPROF “Guerreros Olímpicos” que encabeza el Profr. Roque Guillén Fonseca, donde se dieron una buena cantidad de competidores de todas las categorías, sin logos de agrupaciones, ni colores, lo principal fue el fogueo y convivio de todos.
Por su parte el director técnico de INDEPROFR “Guerreros Olímpicos”, Profr. Roque Guillén Fonseca, se dijo satisfecho por la participación y el haber recibido a los distintos profesores y alumnos participantes de los municipios de San Cristóbal de las Casas, Cintalapa, Villaflores, Berriozabal, Ocozocoautla, Chiapa de Corzo, Tuxtla Gutiérrez entre otros.
ALBERTO CASTREJÓN - EL SIE7E
Con la finalidad de fortalecer el Proyecto de Promoción y Desarrollo del Boxeo Amateur en la geografía estatal, el Instituto del Deporte del estado de Chiapas, en coordinación con la Asociación Chiapaneca de Boxeo, realizaron como evento de arranque, el denominado “Ven y da el Grito”, de Boxeo Estilo Olímpico 2023”, efectuado el 17 de septiembre, dentro del marco del mes patrio.
Juan Aguilar Escobar, presidente de la Asociación Chiapaneca de Boxeo A.C., agradeció el respaldo y confianza de la titular del Instituto del Deporte del estado de Chiapas, Tania Robles Velázquez, para llevar a cabo este plan de promoción y desarrollo del pugilismo chiapaneco en cada rincón de la geografía chiapaneca.
Para la función de boxeo que se realizó en las instalaciones del Centro Integral Romeo “Lacandón” Anaya, ubicado en la colonia San José Terán de Tuxtla
Gutiérrez, se dieron cita un total de 40 peleadores de los distintos gimnasios, provenientes de los municipios de Comitán de Domínguez, Cintalapa, Ocozocoautla, Frontera Comalapa y Tuxtla Gutiérrez.
El también entrenador de boxeo del Instituto del Deporte, resaltó que se dieron cita pugilistas de las categorías pre-infantil, infantil, junior, juvenil y elite en ambas ramas, que intervinieron en un total de 20 peleas pactadas, donde padres de familia y amigos se dieron cita en el inmueble del Romeo Anaya para disfrutar cada una de las acciones.
Enfatizó que en este primer evento de promoción, uno de los propósitos fue que los boxeadores chiapanecos que se encuentran en las categorías de Nacionales Conade y Federados, tengan trabajo de fogueo; también con la finalidad de detectar a los nuevos talentos y pulirlos en su preparación junto a sus entrenadores y metodólogos del Instituto del Deporte.

21 DE SEPTIEMBRE DE 2023 SIE7E DE CHIAPAS 16 DEPORTES
Marcos Borraz, la Reina de la Unión, Valeria I, así como el presidente de Charros de la Capital, Carlos Pastrana.
También estuvo en la mesa de presídium Carlos de Jesús Ber -
Ortiz en busca del playoff
ALBERTO CASTREJÓN EL SIE7E
Asegurar un lugar en el playoff que definirá al monarca de Trucks México Series 2023, no será la única meta del piloto capitalino, Diego Ortiz, durante la décima fecha de la campaña en el óvalo de El Dorado Speedway de Chihuahua, sino que además buscará sumar la victoria para repetir el cetro de la temporada regular.

El volante de la camioneta marcada con el número 19 Orpack-FLEXpremium-PETdeOccidente-Dibagsa-ArmstrongArmored-Intercash-Koa-SRCautomatización-GrupoEmpresarialDeTransportesSalazar-IDconsulto -
res-DYCINSA-LaFlorDeCórdoba-MaeesaServiciosEspecializadosDeTransportaciónYturismo-MROcommsa-FERRIMSSA-BYMindustrial-AislantesyEmpaques-Hidrolock-Sardimex-SanPedroPacific-M&A se hizo de dicho reconocimiento el año pasado y por ello, buscará repetir el logro, aunado a que hasta el momento tiene un espacio en la lucha por el título de la categoría.
“Afortunadamente nos fue muy bien en esta fecha pasada en Aguascalientes, ahora regresamos a Chihuahua donde ya tenemos una victoria”, recordó Ortiz Díaz, quien consiguió la bandera a cuadros en la primera prueba nocturna de este año en Chihuahua.
BOXEO FUTBOL

“Además de que estamos peleando por entrar a playoffs, también buscamos el campeonato de la temporada regular, aún tenemos oportunidad, estamos un poco despegados del primer lugar, pero todavía se puede pelear, y más porque nos tocan fechas donde nos va bastante bien como Chihuahua y Puebla”, externó el capitalino. En ese sentido, el integrante de la escudería Prime Sports, quien ocupa el cuarto puesto en el campeonato de pilotos con 371 unidades, se dijo confiado de lograr el objetivo en el óvalo chihuahuense, debido a que se llevó el triunfo en las dos más recientes ocasiones en ese trazado.
Púas busca la estelar Carrillo instruye en Xochimilco
ALBERTO CASTREJÓN - EL SIE7E
Con una cartelera compuesta en su mayoría por boxeadores regiomontanos, la promotora Round Zero montará este próximo jueves, en el Salón Ribera de Monterrey, Nuevo León, una función encabezada por los pugilistas locales Esteban “Púas” Ibarra y Ángel “Guerrero” Amaro.
Ambos exponentes medirán fuerzas en el combate estelar a seis episodios por el peso súper gallo, en la velada denominada “Poder Regiomontano” de Round Zero Upper Fight presentada por ArmstrongArmored Intercash Aislantes y Empaques, La Flor de Córdoba, FLEX Seguridad Privada y el Restaurant Cluny.
Ibarra (6-0-0), quien debutó en noviembre de 2019 y ha ganado tres de sus seis peleas profesionales por la vía del cloroformo, buscará imponerse a Amaro (5-1-1), para seguir con su calidad de invicto.
“Estamos muy contentos de presentar
esta cartelera que en un 90 por ciento está compuesta por regiomontanos, esto nos hace muy contentos, porque quiere decir que estamos trabajando bien con los boxeadores de seis y cuatro rounds, hay que recordar que somos desarrolladores de talento”, apuntó el promotor de la función, José Antonio “Charro” Hernández.
“En la pelea estelar estarán dos prospectos locales con récords casi perfectos, será una contienda muy pareja, la gente saldrá ganando”, vaticinó el también manager.
Por su parte, el oriundo de San Nicolás de los Garza, Nuevo León, Miguel “Mexicanito” Jiménez (3-0-1) enfrentará en el pleito coestelar al tamaulipeco Antonio “Rapidito” Pérez Martínez (3-2-2), a seis rounds en categoría mini mosca.
“En la semifinal estarán dos peleadores que la gente en Monterrey quería ver, la gente asistente saldrá contenta por el tipo de combate que realizan los dos”, apuntó el empresario, quien agradeció el apoyo de patrocinadores.
AGENCIAS- EL SIE7E
La Comisión Nacional de Cultura Física y Deporte (CONADE), bajo la línea de acción de los Centros del Deporte Escolar y Municipal (CEDEM), en sinergia con la alcaldía Xochimilco y con la presencia del director técnico Mario Carrillo, llevaron a cabo este domingo la cuarta clínica de futbol, que contó con la presencia de más de 62 niños y niñas de entre 12 y 15 años, en el Estadio Valentín González. Carrillo expuso sus conceptos y pidió a los padres de familia de los jóvenes participantes, ir de la mano en busca de la integración, disposición y atención de adolescentes talentosos e interesados en el futbol con la oportunidad de desarrollar sus habilidades. Las clínicas contaron con el apoyo de la directora general de la CONADE,
Ana Gabriela Guevara Espinoza, autorizando balones de futbol profesionales para las clínicas que están dirigidas a niñas y niños de alta y muy alta marginación; el evento también fue encabezado por Arturo Contreras Bonilla, titular de CEDEM y el exfutbolista Gabriel Márquez, así como algunos entrenadores.

Contreras Bonilla presentó la línea de acción de CEDEM, donde cada uno de los jóvenes se concentraron en el entrenamiento con la finalidad de aprender, desarrollar su técnica y habilidades en el fútbol, fomentando la práctica regular y sistemática del deporte a través del aprovechamiento de la infraestructura y los recursos.
Estas clínicas de futbol son gratuitas y se realizan los domingos de 09:00 a 11:00 horas en el Deportivo Xochimilco.
21 DE SEPTIEMBRE DE 2023 SIE7E DE CHIAPAS 17 DEPORTES
NASCAR
Apuntan a “nueva” casa
AGENCIAS - EL SIE7E
América y Cruz Azul se encuentran en pláticas con el Estadio de la Ciudad de los Deportes, en el que actualmente juega el Atlante, ante el cierre del Estadio Azteca, por las remodelaciones rumbo a la Copa del Mundo 2026.
De acuerdo a varias fuentes consultadas, tanto América como Cruz Azul “ya han tenido pláticas con la administración del estadio” en el que juega el Atlante, por la remodelación del Estadio Azteca.

Por su parte, John Sutcliffe, reportó que el Estadio Azteca cerrará en marzo del 2024 para su remodelación, pero América y Cruz Azul dejarán de jugar en el inmueble en enero del próximo año, al finalizar el actual torneo. “Para actividad del América y Cruz Azul, a partir de enero, están en pláticas muy avanzadas con la familia Cosío, que es propietaria del estadio
Ciudad de los Deportes”, informó Jonh Sutcliffe.
Hasta ahora, las autoridades de la Ciudad de México y de la delegación Coyoacán no han entregado ningún permiso de construcción o remodelación relacionado con el Estadio Azteca, aunque están abiertos a entablar charlas para hacerlo posible.
El Estadio Azteca necesita una serie de remodelaciones para cumplir con los requisitos de la FIFA, debido a que el inmueble será sede de la Copa del Mundo 2026, junto con otros recintos de Estados Unidos y Canadá.
Por su parte, FIFA anunció que este miércoles inician las visitas de “planeación” a los 16 estadios que serán sede de la Copa del Mundo 2026, las cuales terminarán en noviembre y en las que el Estadio Azteca está en la agenda, en esas reuniones estarán presentes los “comités organizadores”, además de realizar recorridos por los estadios.
SAN LUIS TIGRES
Confirman cambio de horario Pizarro enciende el Derby
AGENCIAS - EL SIE7E
Atlético de San Luis confirmó el cambio de horario para el duelo ante Cruz Azul correspondiente a la jornada 10 del Torneo Apertura 2023 de la Liga MX en la cancha del Alfonso Lastras Ramírez a través de un comunicado en sus redes sociales.
“El partido entre Atlético de San Luis vs. Cruz Azul, correspondiente a la Jornada 10 del Torneo #Apertura2023, cambia de día y hora. Se realizará el viernes 29 de septiembre a las 21:00 hrs. en el Estadio Alfonso Lastras” informó también la Liga MX a través de su cuenta de X/antes Twitter. Originalmente el encuentro se tenía previsto para el día 1 de Octubre del 2023. Sin embargo se pudo saber que fue el equipo cementero quien fue el que solicitó el cambio de horario del encuentro.
Atlético de San Luis buscarán ganar a Cruz Azul después de perder en las últimas dos jornadas del Torneo Apertura 2023, además de que no han podido vencer a La Máquina en el Alfonso Lastras desde el Torneo clausura 2020. En aquella ocasión, los potosinos eran dirigidos por Guillermo Vázquez y el cuadro tunero venció dos goles por uno al equipo cementero.

En el Torneo Apertura 2020, Atlético de San Luis perdió 1-3,mientras que en el Torneo Apertura 2021 y el Torneo Apertura 2022, empataron a cero goles ante Cruz Azul.
El Atlético de San Luis tendrá dos duelos consecutivos en casa, el primero ante Mazatlán en la Jornada 9, el segundo ante Cruz Azul. El equipo potosino conserva el invicto en casa en este campeonato, de cuatro partidos jugados en el Alfonso Lastras, los potosinos han ganado tres y empatado uno.
AGENCIAS - EL SIE7E
El mediocampista de Tigres, Guido Pizarro, le dio la bienvenida a los refuerzos de Rayados previo al clásico regiomontano, pero dejó en claro los felinos son los actuales campeones del futbol mexicano y tratarán de aprovechar su localía para llevarse el triunfo en la novena jornada del Torneo Apertura 2023.
“Sinceramente me preocupa mi equipo, sabemos la calidad de jugadores que ellos han traído, bienvenidos a la Liga, pero entiendo que tenemos que preocuparnos por nosotros, tenemos un buen equipo, somos los campeones, jugamos en nuestra casa y ojalá podamos conseguir el triunfo”, manifestó.
Dentro de los refuerzos de Rayados para la presente justa del futbol mexicano resaltó la llegada del español Sergio Canales, quien ya lleva cinco goles con el equipo de los cuales tres han sido en la Liga MX.
El otro elemento que destacó en su llegada es Jesús “Tecatito” Corona, quien el pasado fin de semana ya jugó su primer partido en la presente justa con Rayados, equipo al que regresó después de una década.
Guido Pizarro habló también sobre si ayudarán al francés a André-Pierre Gignac a tratar de igualar al ex jugador del Monterrey, Mario de Souza Mota “Bahía”, como máximo anotador de los clásicos regiomontanos luego que está a uno de llegar a 11, y dijo que lo principal es el equipo, pero que será positivo si lo logra el galo.
“Siempre tener esa clase de jugadores que alcancen esos objetivos individuales es importante, también Luis (Quiñones) con mayor asistencias, ojalá lo podamos ayudar también, entiendo que todos están conscientes de que el fin de semana es lograr el triunfo, André está metido en eso, pero ojalá lo podamos ayudar para poder ganar y seguramente disfrutaremos el triunfo”, añadió.

21 DE SEPTIEMBRE DE 2023 SIE7E DE CHIAPAS 18 DEPORTES
SEDE
BEISBOL
Shohei Ohtani es optimista
AGENCIAS -EL SIE7E
La estrella de Los Ángeles Angels, Shohei Ohtani, se sometió a una cirugía de codo el martes y su médico dijo que espera que el japonés de dos vías esté disponible como bateador el día inaugural de la próxima temporada y regrese al montículo como lanzador en 2025.

Ohtani se rompió el ligamento colateral cubital del codo derecho el 23 de agosto, poniendo fin a su temporada de lanzador. Continuó como bateador hasta el 3 de septiembre hasta que sufrió una distensión en el oblicuo.
El médico jefe del equipo de Los Ángeles Dodgers, el Dr. Neal ElAttrache, operó el martes en el Instituto Cedars-Sinai
Kerlan-Jobe en Los Ángeles. ElAttrache realizó una cirugía Tommy John a Ohtani el 1 de octubre de 2018. Ni Ohtani ni el equipo proporcionaron detalles
sobre esta cirugía. “Me sometieron a un procedimiento en el codo esta mañana y todo salió muy bien”, dijo Ohtani en una publicación en
Instagram. “Muchas gracias por las oraciones y amables palabras de todos. Fue muy desafortunado que no pude terminar el año en el campo, pero apoyaré a los muchachos hasta el final. Trabajaré lo más duro que pueda y Haré lo mejor que pueda para regresar al diamante más fuertes que nunca”.
Nez Balelo, agente de Ohtani, emitió un comunicado difundido por los Angels. Balelo no entró en detalles sobre el tipo de cirugía.
“La decisión final y el tipo de procedimiento se tomaron con gran énfasis en el panorama general”, dijo Balelo. “Shohei quería asegurarse de que la dirección tomada le diera todas las oportunidades para
batear y lanzar durante muchos años más”.
Ohtani, de 29 años, lidera la Liga Americana con 44 jonrones y 96 carreras impulsadas, ocho triples y 20 bases robadas. Tuvo marca de 10-5 con efectividad de 3.14 en 23 aperturas, ponchó a 167 y dio 55 boletos en 132 entradas.
“El plan final después de deliberar con Shohei fue reparar el problema en cuestión, y reforzar el ligamento sano en su lugar, mientras se agrega tejido viable para la longevidad del codo”, dijo ElAttrache en un comunicado emitido por los Angels. “Espero una recuperación completa y estará listo para batear sin restricciones el día inaugural de 2024 y hacer ambas cosas (batear y lanzar) en 2025”.
NFL BASQUETBOL
Watson ya es promedio Quiere el oro en casa
AGENCIAS - EL SIE7E
Deshaun Watson no parece un quarterback sereno o de élite. De hecho, nada en él sugiere que sea un jugador por el que se desembolsaron 230 millones de dólares ni que pueda salvar a una franquicia.
Ni de cerca.
Tras dos partidos de su primera temporada completa con los Cleveland Browns, persisten las dudas sobre si Watson puede ser de nuevo el quarterback que lideró la NFL en pases hace tres años con Houston. Menos probable aún parece que pueda convertir a Cleveland en un candidato al Super Bowl. Por ahora, Watson no es siquiera un quarterback promedio. Se ubica cerca del último sitio en la mayoría de las categorías estadísticas principales.
Y en vista de que el corredor estelar Nick Chubb sufrió una lesión en la ro -
dilla izquierda que pondrá fin a su temporada durante la derrota por 26-22 en Pittsburgh, Watson ha perdido a un aliado indispensable en la generación de jugadas.
El mariscal de campo tendrá que hacer incluso más para que el ataque de Cleveland funcione. El problema es que hasta ahora no ha hecho mucho. Watson estuvo simplemente extraviado de principio a fin el lunes frente a los Steelers.

Su pase corto en la primera jugada del partido le rebotó en las manos al ala cerrada Harrison Bryant y fue desviado hacia Alex Highsmith, quien lo devolvió 30 yardas para una anotación que dio a los Steelers la ventaja por 7-0 cuando habían transcurrido apenas 9 segundos.
Y ello marcó la pauta para uno de los encuentros más locos entre estos rivales enconados.
AGENCIAS - EL SIE7E
Victor Wembanyama buscará la medalla de oro con Francia en los Juegos Olímpicos de París.
El novato de los San Antonio Spurs reafirmó el martes su compromiso con la selección francesa en los Juegos de Verano del próximo año en su país de origen.
“Tener un buen desempeño en los Juegos Olímpicos sería una gran historia”, dijo Wembanyama a los medios franceses. “Estaré presente en los Juegos Olímpicos y no hay otro objetivo que el oro”.
Francia llegó a la Copa Mundial FIBA como actual medallista de plata olímpica, pero no logró clasificarse para la segunda ronda. Wembanyama no participó en ese evento, ya que la selec -

ción número uno del draft de la NBA optó por prepararse para su temporada de novato.
“La Copa del Mundo fue muy decepcionante”, dijo Wembanyama. “Pero no tengo ningún juicio que hacer porque no estuve allí”.
os San Antonio Spurs han estado antes en esta situación.
En 1987, después de terminar 28-54, ganaron la lotería del draft y el derecho a seleccionar a David Robinson, un gran hombre generacional de 7’1” (2.16 metros) proveniente de la Academia del Navy.
Una década más tarde, tras una temporada de 20-62, volvieron a ganar la lotería del draft y el derecho a seleccionar a Tim Duncan, un gran hombre generacional de 6’11” (2.11 metros) procedente de Wake Forest.
21 DE SEPTIEMBRE DE 2023 SIE7E DE CHIAPAS 19 DEPORTES
IMAGEN DEL DÍA
LA COLUMNA DE CORCHOLATAS Y REFRESCOS…
ANNETE LEWIS DEPORTE@ SIE7EDECHIAPAS.COM.MX
No, lógico que no vamos a hablar de corcholatas y de la actual directora del Indeporte. Aunque sí podríamos, evidentemente ya el mundo político la dejó a un lado, para beneplático de muchos, no habrá currículum que le respalde y es que lo que sucede a nivel federal con Ana Gabriela Guevara, deja una duda muy razonable con la idea de que un buen deportista puede ser un buen dirigente.
Oja cuando escuche currículum, porque hay depostistas como Aremi Fuentes que, si se trata de medallas y logros, tener una medalla olímpica la haría automáticamente merecedora de la oportunidad de estar al frente de la oficina que controla los destinos del deporte; sin embargo, la competidora está centrada en el ciclo olímpico, en París. Como si no fuera complejo unos olímpicos, la halterista quiere tener dos. Pero hablamos de corcholatas, que parece un término ideal para descubrir a quienes tienen aspiraciones políticas y buscan mantenerse en el foco, hay quienes, en la actualidad, quieren tener por lo menos la posibilidad de estar considerado como la corcholata que se mete debajo de la mesa y aparece cuando la escoba pasa por ahí.


Observa París de reojo Swiatek
AGENCIAS - EL SIE7E
Iga Swiatek (N°2 del mundo) no juega el WTA 1000 de Guadalajara, marcó al torneo de Tokio como su regreso al circuito (25 de septiembre al 1° de octubre), pero no se

detiene y ya piensa en 2024. En una entrevista con Eurosport habló sobre cómo planificará la próxima temporada: “El calendario es muy apretado y tengo muchos torneos importantes por delante. Tenemos el Abierto de Australia
de arranque, citas importantes en Estados Unidos y Roland Garros”.
Sin embargo, el próximo no es un año cualquiera. Es año olímpico y como tal, tiene una cita con la historia: “Los Juegos Olímpicos son claramente una prioridad, pero será complicado llegar en forma óptima a estos torneos, el período de preparación tendría que empezar durante Roland Garros”.
Swiatek, de 22 años, lleva jugados 66 partidos en 2023 (56-10) y ganó cuatro títulos: 250 de Varsovia, 500 de Stuttgart y Doha, y Roland Garros. Actualmente es la N°2 del mundo con 8195 puntos y Paris 2024 será, sin dudas, un objetivo a corto, mediano y largo plazo.
Emiliana Arango está tenien -
do una semana de ensueño y sigue ganando. Esta vez, se metió en cuartos de final del WTA 1000 de Guadalajara. Fue triunfo de la N°180 WTA por 7-5, 1-6 y 6-4 ante Taylor Townsend (N°101 WTA) para ubicarse entre las últimas ocho del torneo. Con este triunfo, subió virtualmente al 120° lugar del ranking mundial.
En la semana ya sorprendió a la N°26 del mundo y cabeza de serie N°11 Anastasia Potapova en la primera ronda para su primera victoria ante una de los 50 mejores, y respaldó con un triunfo aún más enfático sobre Sloane Stephens, que ganó el US Open en 2017 y llegó al N°3 del mundo en 2018, año en el que fue finalista de Roland Garros.

Ya comprobado que el Dios Tláloc y su “estructura” de poco sirvieron y no se empeñen en hacernos creer que hay trasfondo positivo para él, claro, de otra forma no había manera de hacerle ver que el camino no estaba tan allanado como pensó, que esos “puntos” que intentó recuperar con su estructura en su cargo público, no sirvió de nada, porque lo que arrancó apenas hace meses, otros llevan dos sexenios trabajando.
Pero también está pues el caso de la corcholatitas, que no van a alcanzar a destaparse, pero que ya se las llevó la corriente del Dios Tláloc y ahora buscan desesperadamente conseguir algo que los mantenga visibles, están camino a desaparecer.
Ahora bien, de las corcholatas que existen, de las que se supone están en contienda, no existe nadie que pueda ejecutar un perfil deportivo o al menos alguien que lo haya intentado. La gente se desbordó con un video de Salvador Cabañas y con que el “Jaguar” vuelve a rugir, enamorando a los ilusos, pero como estrategia ganó más que un posesionamiento de marketing que se quedó lejos no de un objetivo, sino de tener a las personas idóneas en ese tema.
21 DE SEPTIEMBRE DE 2023 SIE7E DE CHIAPAS
TENIS
Otra de las ausencias
Que tenemos en el atletismo por el castigo a Rusia, es no poder ver a Marina Pirieva, que en varias pruebas es destacada en su país.
Código Rojo
Se le van los frenos a tráiler y se estrella en una bodega
AGENCIAS -EL SIE7E
Tuxtla.- Una supuesta falla mecánica hizo que, un tráiler se enfilara contra el techo de una bodega de café, ubicado sobre la carretera a Villaflores a la altura del Libramiento Sur.

El hecho fue registrado alrededor de las 06:50 horas, cuando un tráiler con caja seca, en color blanco y conducido por Juan Concepción “N”, de 19 años, se
desplazaba sobre la citada vía y en el sentido de Sur a Norte. Sin embargo, al descender, Juan presuntamente quiso disminuir la velocidad y “la mole de acero” no logró detener su marcha. El vehículo comenzó a estrellarse contra diversos postes de telefonía, alumbrados públicos y una barrera de contención.
Finalmente, el tractocamión derribó una malla ciclónica que delimitaba un negocio para luego impactarse
contra el techo de una bodega de café. Juan, fue rescatado por personal del Heróico Cuerpo de Bomberos y elementos de Protección Civil Municipal le brindaron la atención prehospitalaria para luego trasladarlo de urgencia al Instituto Mexicano del Seguro Social ( IMSS) 5 de Mayo.


Cabe precisar que, tomó 9 horas realizar los trabajos de rescate de la unidad motriz y reestablecer las líneas telefónicas en toda esta zona.

DEPORTES
Jueves 21 de septiembre de 2023 www.sie7edechiapas.com
Derrapa pareja a bordo de una motocicleta Detienen a persona por presunto delito de ecocidio en Berriozábal
AGENCIAS - EL SIE7E
Tuxtla.- Una pareja a bordo de una motocicleta sufrieron un accidente de tránsito suscitado sobre el puente Juan Sabines de la colonia Paso Limón.

El reporte fue proporcionado alrededor de las 11:50 horas, cuando elementos de Tránsito y Vialidad Municipal arribaron al citado sitio.
En el lugar, se informó que, una dama embarazada yacía tendida sobre la banqueta.
Los oficiales mencionaron que, minutos antes, la dama iba en compañía de otra persona a bordo de un ciclomotor y de manera sorpresiva terminaron mordiendo el polvo. Sin embargo, el masculino y tampoco la motociclista se encontraron en la escena, empero la dama sí. Pronto, los uniformados solicitaron el apoyo de una unidad de emergencias y en minutos, arribaron paramédicos de Protección Civil Municipal.

Estos, le brindaron la atención prehospitalaria y tras la valoración se indicó que, esta no ameritaba ser llevada a un hospital,
por lo que, quedó al resguardo de sus seres queridos.
Sin poder hacer más al, tanto
COMUNICADO - EL SIE7E
Tuxtla. – La Fiscalía General del Estado ( FGE) a través de la Fiscalía Ambiental detuvo a presunta responsable de transportar material forestal con documentación apócrifa en el municipio de Berriozábal, como parte del operativo Forestal Regional contra la Tala, Tráfico y Comercio Ilegal de Recurso Forestal Maderable.
La detención de María Elena “N” se realizó en el tramo carretero


Tuxtla a San Pedro Tapanatepec a la altura del crucero de la muerte del municipio de Berriozábal, quien transportaba 60
tarimas de madera al parecer pino sin la documentación correspondiente como lo contempla el artículo 99 fracción IV del Reglamento de la Ley General de Desarrollo Forestal Sustentable.
Recurso forestal transportado a bordo del vehículo marca Dodge de color blanco con placas de circulación del estado de Chiapas.
Ante el presunto ilícito, el detenido junto con el material forestal fueron puestos a disposición del Fiscal del Ministerio Público, para determinar su situación jurídica por la probable responsabilidad en el delito de ecocidio.
las autoridades así como los cuerpos de auxilio se retiraron del lugar.
Taxista choca contra un tráiler en San Cristóbal

Cumplimentan orden de aprehensión por pederastia en Arriaga
COMUNICADO - EL SIE7E
Tuxtla.- La Fiscalía General del Estado (FGE) a través de la Fiscalía de Distrito Istmo Costa cumplimentó Orden de Aprehensión en contra de Heber “N”, por su probable responsabilidad en el delito de Pederastia, hechos ocurridos en el municipio de Arriaga. La Fiscalía de Distrito Istmo Costa informó que en las últimas horas elementos de la Policía de Investigación
adscritos a la FGE dieron cumplimiento al mandamiento aprehensorio ordenado por el Juez de Control del Distrito Judicial de Tonalá, en contra del referido imputado por su probable responsabilidad en el delito de Pederastia cometido en agravio de una niña de identidad resguardada. El imputado fue puesto a disposición del Juzgado de Control del Distrito Judicial de Tonalá, donde definirá su situación jurídica en las próximas horas.
VANESA RODRIGUEZ - EL SIE7E
SCLC.- El chófer de un taxi del sitio Bodegas Aurrera, con número económico 0234, terminó chocando en la parte trasera de un tráiler, sobre el Eje Vial 1 de San Cristóbal, la mañana de este miércoles. Aunque hay versiones de que el chofer del taxi venía distraído en el celular que ocasionó el percance, lo cierto es que resultó con lesiones, por lo que fue auxiliado por paramédicos de Pro -
tección Civil, en tanto que personal de Tránsito acudió a deslindar responsabilidades, ya que el argumento fue que el tráiler freno sin previo aviso. Por varias horas el tránsito se vio afectado a 1 carril, ya que esperaron a los aseguradores para el pago de daños. Varios camiones pesados, están circulando por el Eje Vial 1 y parte del Boulevard, ya que actualmente hay remodelación del periférico Sur, lo que hace lenta la vía.
21 DE SEPTIEMBRE DE 2023 SIE7E DE CHIAPAS 22 CÓDIGO ROJO

21 DE SEPTIEMBRE DE 2023 SIE7E DE CHIAPAS 23 PUBLICIDAD
Un estudio constata la extinción de 73 géneros de vertebrados, la mayoría aves
EFE - EL SIE7E
Redacción Ciencia.- Hasta ahora se sabía que el “árbol de la vida” había perdido muchísimas “ramitas” en lo que los científicos han denominado “la sexta extinción masiva” de especies. Hoy, un nuevo estudio advierte de que el árbol ha perdido “ramas” enteras: 73 géneros de vertebrados han desaparecido por completo y, con ellos, el conocimiento que aportan. Con 44 familias extintas, el de las aves es el grupo de vertebrados terrestres más afectado por la acción humana en los últimos cinco siglos (periodo estudiado), seguido de mamíferos, anfibios y reptiles, según una investigación que publica hoy la revista científica Proceedings of the National Academy of Sciences (PNA).
Los autores principales, Paul Ehrlich, profesor emérito de la Universidad de Stanford y Gerardo Ceballos, investigador principal del Instituto de Ecología de la Universidad Autónoma de México y premio Fundación BBVA de Conservación de la Biodiversidad, sostienen sus
conclusiones en el análisis del estado de conservación de 5.400 géneros de vertebrados terrestres (que suman 34.600 especies) entre los años 1500 y 2022.
Los datos usados provienen fundamentalmente de la Lista Roja de especies amenazadas de la Unión Internacional para la Conservación de la Naturaleza (UICN), fruto del esfuerzo colectivo de científicos y organizaciones alrededor del mundo. De acuerdo con la tasa histórica de extinción de géneros, Ehrlich y Ceballos determinan que el
planeta solo habría perdido dos géneros de vertebrados durante los últimos cinco siglos. Sin embargo, la degradación de la naturaleza ha provocado la pérdida de 73 géneros, un ratio de extinción que hubiera tardado 18.000 años en darse de manera natural.
Ceballos incide en que la extinción de géneros enteros de especies posee implicaciones mucho más graves que la de especies.
“Cuando una especie desaparece, otras de su mismo género pueden desempeñar parte de

TECNOLOGÍA
EFE - EL SIE7E
Baltimore.- Las colisiones con barcos y el ruido causado por el motor de los buques son dos de las principales amenazas que afrontan en alta mar los mamíferos cetáceos, como ballenas y delfines, a los que la inteligencia artificial (IA) pretende proteger mediante sistemas de captación de sonido que detecten la presencia de estos animales y avisen a los navíos por donde no deben navegar.
Las costas de Irlanda son el hábitat de hasta 25 especies de cetáceos y son también el lugar donde una ONG ambientalista local está llevando a cabo un proyecto que, gracias a la IA, ha sido capaz de crear un sistema que informa en tiempo real de las zonas donde hay ballenas o delfines.
El objetivo es que las embarcaciones puedan evitarlas, gracias a una iniciativa que pretende “llevar la tecnología a la primera línea de la conservación marina”, según esgrime en una entrevista con EFE la activista Emer Keaveney, fundadora de la asociación ORCA, la ONG irlandesa que implementa el proyecto, bautizado como Smart Whales Sound (Sonido Inteligente de Ballenas).
“La IA está en auge en todo el mundo, pero este proyecto comenzó en 2020, mucho antes de que existiera el ChatGPT. Lo que es
realmente importante es que nos permite analizar muchos más datos, de manera mucho más eficiente”, remarca Keaveney durante una visita de EFE a Baltimore, una pequeño pueblo pesquero al sur de Irlanda, desde donde se ha lanzado este proyecto para proteger a cetáceos. Todo empezó con la instalación en el mar de una boya equipada con un micrófono acuático, llamado hidrófono, que es capaz de detectar sonidos de ballenas a lo largo de una superficie de hasta 80 kilómetros cuadrados y una zona de 13 kilómetros cuadrados en el caso de los delfines.
El océano es un lugar “duro” en el que desarrollar un programa de estas características y “uno de los retos” es que “los equipos sean más robustos y resistentes a las condiciones meteorológicas”, señala el vicepresidente de Huawei en Europa, Kenneth Fredriksen, cuya empresa -con la que EFE tiene un acuerdo de difusión de contenidos- provee la tecnología. Otros deberes pendientes, añade, pasan por entrenar mejor a los algoritmos utilizados en este sistema que detecta el sonido de cetáceos, a fin de que la inteligencia artificial “sea aún más precisa a la hora de evaluar y analizar” los datos que recopila.
“Creo que la tecnología tiene un gran potencial para resolver muchos de nuestros retos
su función en el ecosistema, así como conservar parte del material genético y del potencial evolutivo de la extinta; pero cuando caen géneros enteros la pérdida de biodiversidad es enorme”, apunta el investigador mexicano en un comunicado de PNA. Para entender la trascendencia que supone la pérdida de toda una familia de especies, los autores hacen la comparativa con un árbol: si se cae una sola “ramita” (una especie) las cercanas pueden ramificarse con relativa rapidez y llenar el vacío, de tal manera que la diversidad de especies del planeta permanece más o menos estable.
Sin embargo, cuando se caen “ramas” enteras (géneros) queda un enorme agujero en la cubierta vegetal, una pérdida de biodiversidad que puede tardar decenas de millones de años en “rebrotar” mediante el proceso evolutivo de especiación.
Perder linajes enteros de especies supone, además de dañar el sistema de vida del planeta, perder conocimientos y posibilidades de avances médicos y tecnológicos, que en la mayoría de los casos provienen del estu -
dio de la naturaleza. Ceballos y Ehrlich citan en su estudio el caso de la “rana incubadora gástrica del Sur”, último miembro de un género extinto, cuyas hembras se tragaban sus propios huevos fecundados y criaban renacuajos en sus estómagos, mientras “pausaban” el ácido estomacal.
La extinción de todo este género de ranas hará imposible extraer conocimientos que permitan avanzar en soluciones a problemas de salud como el reflujo gástrico, que puede aumentar el riesgo de cáncer de esófago. Esta “aniquilación biológica masiva” de la que hablan los investigadores, podría ser solo la “punta del iceberg”, ya que los científicos consideran que más del 25 % de las especies del planeta están aún por descubrir, y por tanto “se pueden estar produciendo extinciones en especies que ni conocemos ni conoceremos”.
Para evitar nuevas extinciones y las consiguientes crisis sociales, Ceballos y Ehrlich reclaman “una acción política, económica y social inmediata sin precedentes”.
a una pequeña zona del Mar Céltico. Para la fundadora de ORCA, el objetivo es proteger de los riesgos provocados por la navegación de los barcos al máximo número posible de cetáceos, unas especies cuya supervivencia, subraya Keaveney, depende en gran medida de los sonidos que emiten para comunicarse, porque así es como se organizan, por ejemplo, para cazar o nadar.
medioambientales y de biodiversidad”, zanja Fredriksen, en una entrevista concedida a EFE durante la visita a Irlanda.
Con todo, para que las embarcaciones realmente esquiven las zonas en las que hay presencia de cetáceos, el proyecto Smart Whales Sound requiere de la cooperación de sectores como el de la industria pesquera o el del transporte marítimo, y por ello los ambientalistas de ORCA apelan a la “responsabilidad social corporativa” de todos los actores implicados.
“Queremos llegar a más colaboradores y más inversores para así poder ampliar este proyecto a escala nacional y crear una red de micrófonos de control en el mar a lo largo de toda la costa irlandesa”, detalla la activista Emer Keaveney, que se muestra “ambiciosa” ante el futuro de esta iniciativa, ahora limitada

“La contaminación acústica los perturba y puede enmascarar su comunicación, desplazar a los animales de una zona determinada, causarles estrés crónico y, en el peor de los casos, provocar una reacción aguda que acabe con un animal varado y muerto”, avisa.
La fundadora de ORCA explica que los delfines pueden reconocerse por el sonido, ya que tienen silbidos propios que se asemejan al papel que juegan los nombres propios en el caso de los humanos: “A menudo, los delfines pueden tener compañeros o amistades durante muchos años”.
“Las hembras preñadas cantan sus silbidos una y otra vez para que el bebé en su vientre aprenda cómo suena y, cuando nace, el resto de delfines se callan para que el bebé escuche la llamada de su madre”, señala Keaveney para demostrar que, tanto para humanos como para cetáceos, el sonido es una herramienta clave para sobrevivir.
21 DE SEPTIEMBRE DE 2023 SIE7E DE CHIAPAS 24 INTERÉS GENERAL
ESPECIES
La inteligencia artificial se alía con ballenas y delfines para protegerlos de los barcos
Exitosa participación de la población en el Segundo Simulacro Nacional 2023
COMUNICADO-EL SIE7E FOTO:CORTESÍA
Tuxtla.- Durante la Mesa de Coordinación Estatal para la Construcción de la Paz y la Seguridad, el gobernador Rutilio Escandón Cadenas destacó que el Segundo Simulacro Nacional 2023, con hipótesis de ciclón tropical, lluvias intensas a torrenciales, en Chiapas se realizó con éxito, gracias a la ejemplar participación de las instituciones públicas y privadas y, sobre todo, de la sociedad civil, que se sumaron a estas acciones a favor de la seguridad y el fortalecimiento de la cultura de la prevención.


“Agradecemos la participación del pueblo chiapaneco en el simulacro. Estamos convencidos de que seguiremos un paso adelante en materia de prevención, porque esto nos permite poner en práctica los conocimientos de protección civil, así como reforzar la capacidad
de reacción de las personas cuando se registran situaciones de riesgo por este tipo de fenómeno naturales.
En Chiapas cada vez somos más resilientes”, apuntó.
Sostuvo que el Ejército Mexicano con el Plan DNIII-E, la Marina con el Plan Marina, la Guardia Nacional con el Plan Guardia Nacional, las corporaciones federales, estatales y municipales de seguridad, de protección civil y de salud, y los Comités Comunitarios de Protección Civil, se mantienen en las diferentes regiones de la entidad para auxiliar y salvaguardar a la población ante cualquier contingencia. Escandón Cadenas informó que las lluvias continúan en la entidad, por lo que insistió en el llamado a no bajar la guardia, atender las recomendaciones preventivas, alejarse de los ríos, arroyos y las montañas, ante el peligro de inundaciones y deslaves, extremar precauciones al transitar en carretera
y en caso de alguna emergencia trasladarse a los refugios temporales. Asimismo, el mandatario dio a conocer que siguen los recorridos casa por casa para realizar labores de fumiga -
ción a fin de erradicar el mosquito del dengue, zika y chikungunya, sin embargo, dijo, es fundamental que las y los chiapanecos se sumen a las acciones de prevención en los hogares. En este sentido, exhortó a mantener limpios los patios, banquetas, conductos de agua y las alcantarillas, desechar cacharros, sellar bien los recipientes de agua para combatir la propagación del mosquito y evitar enfermedades transmitidas por estos vectores.
“Seguimos insistiendo en este rubro porque se ha detectado una variante del mosquito del dengue que hace muchos años no se registraba en México, pero principalmente en Chiapas, debido al factor de la frontera sur. Así que hay que cuidarnos. Aunque todas las autoridades hacemos lo que nos corresponde para combatir y eliminar estos vectores, necesitamos el apoyo y la solidaridad de todos. Cuídate y protege a tus seres queridos”, manifestó.
21 DE SEPTIEMBRE DE 2023 · SIE7E DE CHIAPAS 25 ESTATAL
MESA DE SEGURIDAD
•El gobernador informó que está por iniciar la temporada de frentes fríos, que generan presencia de lluvias, fuertes vientos y bajas temperaturas

21 DE SEPTIEMBRE DE 2023 SIE7E DE CHIAPAS 26 26 ESTATAL
CATHERINE BLOCH
Los acervos también sirven para valorar la pluriculturalidad de los pueblos
REDACCIÓN-EL SIE7E FOTO:CORTESÍA
Tuxtla.- Como parte de las actividades que el proyecto Acervo Chiapas Visual y Sonoro realiza para difundir la importancia de la conservación, difusión y preservación de los acervos, se llevó a cabo el conversatorio ¿Los archivos custodian nuestra memoria?, en el que se contó con la destacada participación de Catherine Bloch, quien aseguró que los acervos también sirven para valorar la pluriculturalidad de los pueblos, para contribuir a generar un mayor entendimiento, aceptación y respeto entre iguales. En su conferencia virtual, ante estudiantes de la Universidad Autónoma de Chiapas y público en general, la especialista disertó sobre archivos, documentos y memoria del mundo. Catherine Bloch, experta en el
tema, inició su exposición destacando que “los archivos son depositarios de la memoria de los pueblos y esta debe ser accesible para la memoria de las y los ciudadanos”, al continuar su disertación acerca de la importancia de los documentos, explicó que estos son objetos con contenido informativo, analógico o digital y el soporte en el que se consigne. Los documentos, aseguró, tienen valor significativo y duradero para una comunidad, una cultura, un país o para la humanidad en general y su deterioro o pérdida supondrían un empobrecimiento perjudicial, ya que constituyen un medio primordial de conocimiento, creación y expresión. En otro momento, Bloch se refirió a la preservación y accesibilidad y detalló que el patrimonio documental engloba toda clase de documentos: manus-
critos, impresos, sonoros, fílmicos, fotográficos y digitales, así mismo se refirió al proyecto de la Organización de las Naciones Unidas para la Educación, la Ciencia y la Cultura (UNESCO), Memoria del mundo, creado por el organismo internacional para ocuparse del rescate y preservación del patrimonio documental mundial y apoyar el acceso universal al patrimonio documental mediante el uso de tecnologías de la información.
Catherine Bloch es originaria de la Ciudad de México, es maestra en Relaciones Internacionales por la UDLA; ha sido investigadora en El Colegio de México y en el Departamento de Asuntos Internacionales del Instituto Mexicano del Seguro Social, fue becaria Fullbright. Actualmente es presidenta del Comité Mexicano de Memoria del Mundo de la UNESCO
CRIMEN ORGANIZADO EN LA TRINITARIA
RUBÉN PÉREZ-EL SIE7E FOTO:RUBÉN PÉREZ
Tuxtla.- Uno de los compromisos de la Cuarta Transformación, encabezada por el presidente del país, Andrés Manuel López Obrador, era brindar seguridad a todos los ciudadanos, “por eso ahora le pedimos que voltee a ver a Chiapas, necesitamos que nos dé seguridad”.
Así lo manifestó Hortensia Méndez, madre de familia originaria de La Trinitaria e integrante de la Unión Nacional de Trabajadores Agrícolas (UNTA), quien lamentó que, en su municipio, ubicado en la región Fronteriza de Chiapas, se haya agudizado las extorsiones ante la presencia del crimen organizado.

Comentó que los “levantones”, cobro de piso y otros delitos han aumentado en los últimos tiempos, “ya basta de la inseguridad que vivimos, porque esas amenazas vienen de los cárteles, nos intimidan, y por eso muchos compañeros han caído”.
Destacó que muchas veces la gente no denuncia porque tiene miedo, sin embargo, comentó que se han organizado con sus dirigentes de la Unión para continuar con la lucha y exigir que esa agrupación sea frenada por las autoridades.
“Ya no queremos que haya más desapariciones, más muertes, que la gente no sea hostigada; vivimos con un terror inmenso, no tenemos paz, no hay se-
guridad para nuestros hijos, y cuando estos salen, no sabemos si volverán”, sostuvo.
Recordó el caso de la maestra Berni Flor Mejía, desaparecida y asesinada el pasado 12 de septiembre en Amatenango de la Frontera, “salió de su casa en la mañana del 7 de septiembre, se despidió de sus hijos, y ya no regresó; por eso pedimos a la autoridad que actúe”. Dijo que, tan grave es el asunto, que sólo ella conoce de al menos una docena de casos de personas desaparecidas, “casos que no son denunciados por sus familiares porque hay temor a represalias; además, tenemos a tres ‘levantados’ de la UNTA”.
Desde hace 10 días, dejó en claro, hay bloqueos carreteros desde La Trinitaria hasta San Gregorio Chamic, Frontera Comalapa, lo que ha generado desabasto de insumos, “la situación es complicada desde hace como tres años”.

(2017-2022) y es integrante del Comité Consultivo Internacional del Programa Memoria del Mundo de la UNESCO.
Si desea ver la conferencia de manera íntegra, se encuentra disponible en: https://fb.watch/ nboXVxKkHS/

CONFLICTO SOCIAL
Bloquean por varias horas el tramo carretero de Teopisca a Comitán
VANESA RODRIGUEZ-EL SIE7E FOTO:VANESA RODRIGUEZ
SCLC.- Por más de 4 horas, pobladores de la Comunidad Cruz Quemada, Municipio de Amatenango del Valle mantuvieron un bloqueo carretero sobre el tramo de Teopisca a Comitán de Domínguez, lo que afectó a cientos de vehículos.
Los manifestantes, pedían a la Presidenta Municipal Andrea Díaz Martí -
nez, y síndico Carlos Gómez López, les regresen los proyectos productivos que les corresponde, ya que de años atrás, no los han considerado. Los manifestantes fueron llamados a negociar con funcionarios del gobierno, con la condición de dejar libre la vía, y con ello poder comenzar a tocar instancias encargadas en cada uno de los proyectos productivos que actualmente el gobierno ofrece a las comunidades.
21 DE SEPTIEMBRE DE 2023 · SIE7E DE CHIAPAS 27 ESTATAL
“Necesitamos que el presidente AMLO nos dé seguridad”: madre de familia de la UNTA
Descubren un tiburón de 500 años, el vertebrado más longevo del mundo
AGENCIA ID -EL SIE7E FOTO:AGENCIA ID


CDMX.- Un increíble hallazgo se dio por accidente en las costas de Belice. Mientras iban en busca de otra especie, un grupo de investigadores se topó con un tiburón de Groenlandia que tiene alrededor de 500 años de edad. Además de destacarse por la longevidad, llamó la atención encontrar este ejemplar en las aguas cálidas del Caribe, lejos de su hábitat natural.
Si bien no es algo habitual, en ocasiones se realizan descubrimientos por accidente. Esto fue lo que ocurrió con el equipo del laboratorio de Ecología y Conservación de Depredadores de la Universidad Internacional de Florida, que gracias a un hecho fortuito pudo analizar una especie de tiburón que tiene siglos de antigüedad.
Durante la expedición en las costas de Belice, el objetivo de los biólogos era estudiar el comportamiento de los tiburones tigre. En eso se encontraban cuando inesperadamente se toparon con una especie antiquísi -
ma, que no se veía hacía años. De acuerdo a la publicación de la revista científica Marine Biology, en un comienzo sospecharon que se trataba de un tiburón de seis branquias, pero al mirar en detalle notaron que se trataba de un tiburón de aguas frías.

Descrito por quienes observaron el ejemplar como una “criatura lenta” que estaba bajo la superficie, resultó ser un tiburón de Groenlandia. Como bien lo indica su nombre, suele hallarse en el norte del océano Atlántico y el océano Glacial Ártico, cerca de las costas de Groenlandia e Islandia.
Según un estudio de la Universidad de Copenhague, que fue publicado en 2016 en la revista Science, el tiburón de Groenlandia es considerado como el vertebrado más longevo del mundo. La especie tiene una esperanza de vida de 500 años, que en algunos casos hasta puede extenderse durante una década más. Por eso, y dadas algunas características en particular, se estima que este ejemplar podría haber nacido en el siglo XVI.
A lo largo de la historia, las investigaciones sobre esta especie arrojaron que la extensión de su vida puede deberse a las lentas condiciones de desarrollo. Dado que solamente crece un centímetro por año y que la madurez sexual puede tardar más de un siglo en alcanzarse, todos los procesos se alargan, por las bajas temperaturas de las aguas en donde habitan, y eso da como resultado una esperanza de vida mucho más
larga que el promedio. Con una existencia que usualmente se desarrolla en profundidades de hasta 2000 metros, estos tiburones son señalados por su lentitud para desplazarse. Además, en muchos casos tienen una ceguera parcial que es causada por un parásito que consume su tejido ocular. Usualmente, se alimentan de peces, calamares y mamíferos marinos, como por ejemplo focas.
21 DE SEPTIEMBRE DE 2023 SIE7E DE CHIAPAS 28 28 ESTATAL INTERÉS GENERAL HALLAZGO
Última hora Canacintra denuncia afectación millonaria por migrantes y crisis en la frontera de México
Estados Unidos cerró el lunes pasado uno de los tres cruces de carga comercial para destinar su personal a procesar migrantes, cuya llegada se ha multiplicado en el último mes.
EFE
EL SIE7E
FOTO: EFE
Ciudad Juárez.- La Cámara Nacional de la Industria de la Transformación (Canacintra) denunció este miércoles afectaciones por cerca de 500 millones de dólares (unos 468 millones de euros) en la frontera norte de México por la suspensión de trenes de carga ante el incremento de migrantes y fallas en la Aduana Mexicana. Thor Salayandía Lara, vicepresidente nacional de Maquiladora y Franjas Fronterizas de la Canacintra, dijo a los medios que están “varados” 500 millones de dólares en exportaciones en la frontera de Ciudad Juárez con la urbe estadounidense El Paso, Texas. El representante del sector privado explicó que Estados Unidos cerró el lunes pasado uno de los tres cruces de carga comercial para destinar su personal a procesar migrantes, cuya llegada se ha multiplicado en el último mes.


Añadió que el sistema de la Aduana Mexicana tiene fallas, por lo que las exportaciones se procesan manualmente, y eso ha ralentizado el proceso, Además, abundó, la empresa ferroviaria Ferromex anunció el martes frenaría sus trenes de carga a Ciudad Juárez tras detectar más de 4.000 migrantes en carros o vías férreas a nivel nacional. Mientras que, del otro lado de la frontera, denunció que el Gobierno de Texas implementó revisiones a cada vehículo de carga que entra en territorio texano para buscar migrantes.
“Nosotros hacemos un conteo de todo lo que se deja de cruzar por carretera, de todo lo que viene del sur con estos trenes y estamos hablando de 500 millones de dólares diarios. Es una afectación económica muy fuerte”, dijo el líder industrial. Un análisis realizado por la Canacintra con datos del Departamento de Transporte de Estados Unidos y del Instituto Nacional de Estadística y Geografía (Inegi) señala que cada carga que pasa por Juárez lleva una media de 135.000 dólares en mercancía.
En esta temporada, añadió, en promedio
México prevé 56 frentes fríos en la temporada 2023-2024
como oleaje elevado en el litoral del Golfo de México”.
Dijo que en el litoral del Golfo de México, estos fenómenos ocasionan vientos intensos del norte y oleaje elevado, lo que se conoce como evento de norte.
cruzan 3.429 cargas por día.
Salayandía Lara explicó que entre las fallas de la Aduana Mexicana, las revisiones de los texanos y el cierre del cruce en el puente Córdova-Américas, la crisis derivada de la gestión migratoria se está convirtiendo también en una crisis de comercio exterior.
Manuel Sotelo Suárez, presidente de la Asociación de Transportistas de Carga de Ciudad Juárez, dijo que el lunes y el martes toda esta situación detuvo la mitad de las cargas, una situación que no se ha normalizado por completo.
“Se me hace muy tardada la experiencia y el calorón que no se aguanta, aquí estamos parados. Llegué a las 7 de la mañana y ahorita ya llevo casi 6 horas”, dijo Víctor Sánchez, un chofer.
“Nos dicen que por los indocumentados están haciendo todo esto y nos afecta a nosotros. La maquila está perdiendo mucho dinero y nosotros también”, agregó mientras esperaba fluir en una fila de al menos 20 kilómetros de cargas varadas.
ADUANAS
Suspenden temporalmente revisión de vehículos en frontera de Texas para procesar migrantes
EFE
EL SIE7E
FOTO: EFE
Ciudad de México.- Las autoridades mexicanas previeron este miércoles que ingresen al país 56 frentes fríos en la temporada 2023-2024, que inicia en septiembre y concluye en mayo, según los pronósticos del Servicio Meteorológico Nacional (SMN).
Además, el SMN puntualizó que en enero y febrero de 2024 se registrarán la mayor cantidad de sistemas frontales de la temporada, que será similar a la del año anterior.
La coordinadora del SMN, Alejandra Méndez Girón, adelantó en un comunicado que para septiembre de 2023 se pronostica el ingreso de tres frentes fríos, para octubre otros cinco, para noviembre cinco más y para diciembre otros ocho.
En tanto, en enero de 2024, se estima el arribo de 10 sistemas frontales, en febrero nueve, en marzo siete, en abril seis y en mayo tres.
Recordó que en la temporada pasada se registraron 55 frentes fríos y, para la temporada 2023-2024, se pronostica el arribo de 56 sistemas frontales que provocan descenso de temperatura y heladas.
La titular del SMN detalló que “climatológicamente, se registran mayores descensos de temperatura en Ciudad de México, Chihuahua, Durango, Estado de México, Puebla, Tlaxcala y Zacatecas”.
Enfatizó que, durante este periodo, “las masas de aire frío provenientes de Canadá y Estados Unidos se desplazan a México provocando marcados descensos de temperatura, vientos fuertes y lluvias, así
“Cuando las masas de aire frío avanzan hasta el Istmo y Golfo de Tehuantepec, generan viento del norte muy fuerte, que puede superar 100 kilómetros por hora y oleaje elevado”, expuso.

Mientras que en la península de Yucatán, afirmó, se registra disminución de las temperaturas, vientos fuertes y lluvias.
Enfatizó que, cuando las masas de aire frío interactúan con humedad, pueden llegar a provocar nevadas en el noroeste de México, incluyendo Baja California, el norte, noreste y el centro del país.
Adelantó que para la temporada 2023-2024 se pronostican de nueve a 11 tormentas invernales, con mayor ocurrencia en diciembre y enero.
Finalmente, detalló que también se presentarán las nieblas y neblinas, que disminuyen la visibilidad en los caminos, carreteras, ciudades y aeropuertos de las regiones, por lo que recomendó a la población estar atenta a los avisos de la Comisión Nacional del Agua (Conagua), el SMN y Protección Civil.
Los Ángeles.- La Oficina de Aduanas y Protección Fronteriza de EE.UU. (CBP) suspendió temporalmente desde este miércoles el procesamiento de vehículos y carga de trenes en uno de los accesos del paso internacional de Eagle Pass (Texas) para apoyar el proceso de los migrantes detenidos en la frontera.
En un comunicado de prensa, CBP explicó que necesitaba redireccionar a su personal para ayudar a la Patrulla Fronteriza a detener la afluencia de migrantes en ese sector.
“Continuaremos aumentando todos los recursos disponibles para procesar a los migrantes de manera expedita y segura”, agregó la agencia.
La suspensión temporal de pro -
cesamiento de vehículos afecta el Puente 1 del puerto fronterizo para vehículos y el puente ferroviario que comunica Piedras Negras (México) con Eagle Pass. CBP también suspendió desde el pasado lunes el procesamiento de carga en el puerto de entrada del Puente de las Américas (BOTA) de El Paso (Texas), que suele estar abierto desde las 6 de la mañana hasta las 2 de la tarde de lunes a viernes. La suspensión temporal también se ordenó para enviar a los agentes a ayudar a la Patrulla Fronteriza del sector de El Paso a procesar a los migrantes. CBP aclaró que “planifica y ejecuta periódicamente medidas de contingencia, como estas, para apoyar la misión de la agencia y garantizar la seguridad y el bienestar de quienes se encuentran bajo la custodia de la agencia.

21 DE SEPTIEMBRE DE 2023 · SIE7E DE CHIAPAS 29 ÚLTIMAESTATAL HORA
SMN EFE
EL SIE7E FOTO: EFE
INTERÉS GENERAL
De
México
para el mundo:
los inventos más importantes del país norteamericano
AGENCIA ID -EL SIE7E FOTO:AGENCIA ID
CDMX.- La inventiva del ser humano ha marcado una diferencia con relación a otras especies. Gracias a la creatividad e inteligencia de algunos hombres y mujeres, la humanidad ha experimentado un apoyo clave para facilitar procesos cotidianos, dar opciones recreativas y seguir alimentando el desarrollo. Al respecto, hay países que destacan más que otros cuando de este tipo de aportaciones de trata. Sin embargo, fuera de esas naciones que podrían llegarnos a la mente, si investigamos, veremos que otros lugares del planeta también han participado a favor del conocimiento, la tecnología y la comodidad de la contemporaneidad. Así, llegamos a México, un país de grandes ideas que han sido aterrizadas en inventos de popularidad global. Los principales inventos mexicanos
Televisión a color (1940)
Sin duda, no hay manera de abordar el tema de los inventos mexicanos dejando de lado la televisión a color. El responsable de esto fue el ingeniero Guillermo González Camarena, quien patento un sistema que utilizaba los colores primarios para la captación y reproducción de imágenes.

inventos mexicanosEs necesario apuntar que la historia que nos llevaría hasta la televisión a color tuvo otros protagonistas. Están, por ejemplo el ingeniero ruso, Vladimir K Zworykin, y el estadounidense, Peter Goldmark. Ambos lograron obtener patentes de sistemas de televisión a color, incluso antes que el mexicano. No obstante, para los años 60, González Camarena consiguió aumentar su aporte, pues inventó un sistema bicolor simplificado, mucho más simple y económico. De
ALGO MÁS
QUE PALABRAS
hecho, esto sería utilizado por la NASA durante la misión Voyager de 1979. México celebra el Día del Inventor cada 17 de febrero, en honor al natalicio de Guillermo González Camarena.
Píldora anticonceptiva (1951)
La primera pastilla anticonceptiva oral del mundo fue ideada por el químico mexicano Luis Ernesto Miramontes. Este hecho obtuvo tal reconocimiento que logró que el experto sea el único ciudadano de ese país en estar en el USA Inventors Hall of Fame.
El trabajo consistió en sintetizar la noretisterona o noretindrona. La patente la obtuvo Luis Ernesto Miramontes, junto a Carl Djerassi y George Rosenkranz, miembros de la compañía química mexicana Syntex. De acuerdo con la Academia Mexicana de Ciencias, Luis Ernesto Miramontes es el científico mexicano de mayor trascendencia del siglo XX.
Pintura antigrafiti (2001)
A principios del milenio, el Instituto de Física de la Universidad Nacional Autónoma de México (UNAM) desarrolló la pintura antigraffiti. Aquí no destaca un único nombre, sino que la innovación corresponde a un grupo de investigadores del Departamento de Física Aplicada y Tecnología Avanzada. inventos mexicanosEsta es una pintura única, la cual contiene un agente que no permite que la sustancia se mezcle con agua. Según Fundación UNAM, “la solución fue creada a partir de nuevas moléculas de polímeros, mismas que tenían dos características principales: la hidrofobia (rechazo al agua) e hidrofilia (gusto por el agua)”. El desarrollo en cuestión es una marca registrada bajo el nombre de Deletum 3000.
LO ARMÓNICO COMIENZA POR UNO MISMO
“Es evidente que la sociedad actual no hallará una solución al problema si no revisa seriamente sus modos y maneras de latir, el valor estético de la creación, el contacto con sus semejantes, la comunión de pulsos y latidos en pro de un mundo más pacífico”.
VÍCTOR CORCOBA HERRERO-EL SIE7E corcoba@telefonica.net
El mejor partido existencial es el que uno juega consigo mismo. Todos deseamos la paz, pero apenas trabajamos la justicia para defender la vida, ni tampoco abrazamos lo armónico que germina de lo auténtico y se desarrolla con un ánimo autónomo, despojado de intereses mundanos. Sin duda, el cambio tiene que producirse desde el propio ser de cada cual. Hemos de salir de este caos de enormes desigualdades e injusticias, para entrar en concordia con todo lo que nos rodea, despojados del virus egoísta, que todo lo enferma de inútiles batallas. Es un deber de toda la comunidad humana, por consiguiente, huir de comportamientos contaminados por el vasallaje. El respeto es esencial, ya no solo para movernos y cohabitar, también para entrar en relación y poder convivir. Hay que tomar el pulso al mundo. Es evidente que la sociedad actual no hallará una solución al problema si no revisa seriamente sus modos y maneras de latir, el valor estético de la creación, el contacto con sus semejantes, la comunión de pulsos y latidos en pro de un mundo más pacífico. Sabemos que juntos podemos contribuir a hacer un planeta más de todos y de nadie en particular. El futuro nos pertenece y ha de ser más ecológico, equitativo, justo y seguro. Desfallecer en este objetivo es comenzar a morir en cada aurora. El odio no es una opción. Hoy más que nunca hace falta poner fin a todas las contiendas, incluida la guerra contra la naturaleza, con sus malvados efectos en las diversas crisis que representan el cambio climático, la contaminación y la pérdida de biodiversidad. Ante esta compleja situación, quizás el mejor propósito sea llenar nuestras miradas con espacios de luz y sosiego, para no caer en la desolación. Los espacios terrícolas, con sus moradores en humanitarios vínculos, tienen que dejar de enfrentarse y han de marchar hacia la quietud posible y deseable. La historia es nuestra, y a poco que hagamos un
repaso por ella, percibiremos que el ruido de las contiendas nos ha dominado. Considero, pues, que ha llegado el momento de injertarnos en las entretelas una tregua ilimitada, de activar los gestos sistémicos, comenzando por abordar el hambre que viola de manera flagrante los derechos humanos. Desde luego, si nos consta que todos perdemos en una corporación en la que cohabita la desconfianza, la intolerancia y el rencor, lo justo es combatir unidos, corazón a corazón esta tremenda catástrofe. Indudablemente, el tema de lo integral como valor que nos hermana, nos exige lealtad de miras y conciencia responsable consigo mismo. Necesitamos, en consecuencia, que esta interrelación se motive con imperativos éticos. En este sentido, el camino de la solidaridad y del diálogo, cuando menos para aminorar tensiones y poder avanzar hacia otros horizontes más cooperantes, es fundamental para que progrese el soplo fraterno, procurando asegurar la asistencia, con la convicción de que el verdadero amor es el único motor que puede hacer un mundo más habitable para todos. Quizás antes tengamos que escuchar el grito de esas gentes martirizadas, para poder despertar a la plena correspondencia entre nosotros, bajo el lenguaje de la conciliación reconciliada. Lo que no concuerda es la falsedad. Estamos necesitados del resplandor de la verdad, de hacer la paz en las pequeñas cosas de cada día, con espíritu renovado y con la fortaleza necesaria para poner fin a ese legado destructivo de armas que nos enturbian los caminos, con una prohibición jurídicamente vinculante de los ensayos nucleares y con el impulso de otros modelos de prevención como la diplomacia preventiva, que aborde todas las formas de violencia. Puede que tengamos que reforzar, además, las operaciones solidarias y abordar la imposición del acuerdo, mediante el cultivo de la palabra, del arte o de la ciencia. Lo importante es no desfallecer en el acercamiento, libre de todo aislamiento, porque el esfuerzo por juntarse no conoce de fronteras ni tampoco de la necedad de los frentes.
21 DE SEPTIEMBRE DE 2023 SIE7E DE CHIAPAS 30 30 ESTATAL
Nerviosismo
*El Paquete Económico 2024 Busca Asegurar el Estado de Bienestar: SHyCP
*Posicionamientos Encontrados, Durante la Comparecencia de Rogelio Ramírez
MIGUEL BARBA-EL SIE7E
Ante el Pleno de la Cámara de Diputados y con el propósito dar inicio al análisis del Quinto Informe de Gobierno del presidente de la República, compareció el titular de la Secretaría de Hacienda y Crédito Público (SHCP), Rogelio Ramírez de la O, para referirse a la política económica del país y dar cuenta del Paquete Económico para el Ejercicio Fiscal 2024.
La presidenta de la Mesa Directiva de la Cámara de Diputados, Marcela Guerra Castillo (PRI) tomó la protesta de decir verdad al funcionario.
En su intervención inicial, el titular de la SHCP destacó que el Paquete Económico 2024 busca dar continuidad a la consolidación de un estado de bienestar y plantea lineamientos de política económica prudentes y alineados con el Plan Nacional de Desarrollo 20192024, en un entorno de finanzas públicas sanas, con un nivel de deuda estable y sostenible, hechos que garantizarán una transición ordenada hacia la siguiente administración.
Para 2024, relató, se estima que la economía mexicana crezca en un rango de 2.5 a 3.5 por ciento real anual, lo cual está sustentado en la fortaleza de factores domésticos como el consumo y el empleo, en conjunto con inversión pública y privada. Se propone un gasto neto total de 9 billones 22 mil millones de pesos para 2024, lo que representa 26.4 por ciento del Producto Interno Bruto.
El gasto programable propuesto es de 6.5 billones de pesos y el gasto no programable es de 2.6 billones de pesos. El costo financiero estimado asciende a 1.3 billones de pesos. Se prevé un gasto federalizado de 2 billones 563 mil millones de pesos, que implica un crecimiento de 0.5 por ciento en términos reales; el pago de participaciones por un billón 267 mil millones de pesos y de aportaciones por un billón 68 mil millones de pesos.
Ramírez de la O afirmó que en el proyecto de Presupuesto 2024 se priorizan los programas sociales dotándolos de recursos para entregarlos de manera directa y sin intermediarios. Destaca el incremento del monto del programa Pensión para el Bienestar de las Personas Adultas Mayores a 6 mil pesos bimestrales para cada beneficiario.
Precisó que en lo que va de la actual administración, el gasto en protección social ha aumentado 40 por ciento real con respecto a su nivel en 2018, lo que ha tenido un efecto positivo en los hogares mexicanos. Entre 2018 y 2022, cinco millones de mexicanos salieron de la pobreza y por primera vez en la historia el porcentaje de la población en esta condición es menor al 40 por ciento.
Además, dijo, hay un aumento histórico al salario mínimo por 90 por ciento en términos reales desde el inicio de la administración y la eliminación de la subcontratación. Este año, se registraron las tasas de desempleo más bajas desde que se tiene registro, con un nivel promedio de 2.8 por ciento. En lo que va de la administración se han creado 5.9 millones de empleos.
Indicó que se estima que al cierre del año en curso la deuda pública alcance un nivel de 46.5 por ciento del PIB, que representa un aumento de 2.8 puntos porcentuales respecto a su nivel de 2018. Este incremento es casi una tercera parte del aumento promedio de 8.2 puntos porcentuales del PIB observado en las dos administraciones anteriores.
Política económica integral enfocada en superar los rezagos
En los posicionamientos, el diputado Manuel Guillermo Chapman Moreno (Morena) mencionó que el Ejecutivo Federal ha implementado una política económica integral enfocada en superar los rezagos sociales, crear nuevos empleos y mejorar las condiciones de vida de todas las personas. La eliminación del dispendio, el combate frontal contra la corrupción,
una planificación económica sólida y la aplicación de políticas públicas hacendarias “han permitido que los recursos públicos se destinen en beneficio de la sociedad”.
La diputada de Morena, Alejandra Pani Barragán, expuso que las políticas públicas del gobierno han permitido un crecimiento económico sostenido y la política social ha reducido la brecha de desigualdad de ingresos. “Hoy la economía de México está en franca recuperación”, ya que el primer semestre de 2023 presentó un incremento de 3.6 por ciento respecto al periodo del año anterior. Este dinamismo se debe a que el salario mínimo acumuló un crecimiento de 86 por ciento en términos reales.
Hay muchas mentiras en el Paquete Económico 2024 El diputado Carlos Alberto Valenzuela González (PAN) destacó que en este Paquete Económico 2024 hay muchas mentiras estadísticas; están poniéndole sobrenombre a la deuda, al decirle balanza fiscal, pero es deuda. “En este paquete les recetan a las y los mexicanos dos billones de deuda a cambio de quitarle recursos a las farmacias del ISSSTE, a las guarderías del Seguro Social, a la red nacional de transmisión de CFE; esos recursos los quieren para la política de reconstrucción del tejido social, así le llaman al acarreo de la Secretaría de Bienestar y a la compra de votos”.
Patricia Terrazas Baca, diputada del PAN, señaló que la deuda es deuda, se le llame como se le llame, pues “estamos en tiempo de vacas flacas por la mala administración que existe”. La austeridad que tanto se ha presumido en este presupuesto y en otros, dijo, solo queda en discurso. “Nosotros vamos a luchar por el campo, por los caminos y las carreteras del país, por las actividades productivas y por la salud. Se ha endeudado a México y se ha dejado en la miseria a más mexicanos de los que ustedes presumen haber sacado de la pobreza”.
Presupuesto 2024 no contiene crecimiento económico
La diputada Alma Carolina Viggiano Austria (PRI) afirmó que el Paquete Económico para 2024 es ficticio porque está diseñado sobre bases que no son reales; es ineficiente al endeudar al país, al transitar de 10.5 billones en 2018 a 16 billones para 2024. El presupuesto no contiene crecimiento económico, afecta la inversión, no tiene perspectiva de género, hay datos engañosos en materia de salud, no contempla acciones para la economía familiar ni programas para el empleo ni para el campo.
También del PRI, el diputado Ildefonso Guajardo Villarreal indicó que el Paquete Económico 2024 viola la Constitución en cuanto al incremento de deuda, y nos pone en la ruta del proceso de una posible crisis; en este paquete mienten, traicionan y roban. “Tenemos en nuestras manos la posibilidad de hacerle cambios a esta propuesta del gobierno; el gasto reprimido no puede ser por siempre”. México se posicionó como eje para la inversión extranjera Por el PVEM, el diputado Luis Armando Melgar Bravo consideró que las estimaciones de las variables económicas son prudentes, responsables y acordes al contexto que se presenta a nivel nacional e internacional. Refirió que el Paquete Económico 2024 es responsable, económica y socialmente, tanto por el lado de ingresos como por el de egresos. “Es prudente en sus estimaciones macroeconómicas e impulsor del desarrollo”.
Resaltó que en estos últimos años se han visto avances relevantes en esta materia, entre los que destacan la tasa de crecimiento económico alcanzada, el peso mexicano como la divisa más fuerte y fortalecida en el mundo, se recuperó el poder adquisitivo del salario mínimo, se mantuvieron los niveles de la deuda en rangos sostenibles y México se posicionó como el eje de atracción para la inversión extranjera mundial.
El acoso e investigación por parte del partido en el poder en contra de la virtual candidata a la Presidencia de la República por el Frente Amplio por México, senadora Xóchitl Gálvez, es del tamaño del temor que existe ante un eventual triunfo suyo el próximo 2 de junio del 2024.
Los militantes y simpatizantes de MORENA mantienen la persecución en contra de la hidalguense, con el fin de exhibirla, denostarla y descarrilar su imagen que hasta este momento y pese a todo, se mantiene en el ánimo del bloque opositor, el cual parece estar decidido a respaldar a Xóchitl Gálvez hasta donde llegue. Es necesario dejar en claro que la guerra sucia y de lodo que ya se vive en los dos frentes políticos, ha generado un ambiente ríspido y peligroso, donde la violencia podría aparecer en cualquier momento manchando con ello la competencia electoral que se vivirá el próximo año.
De las cinco o seis acusaciones hechas en contra de la hidalguense, ninguno la cimbró. Si supera la denuncia sobre un posible plagio en su trabajo para titularse, Gálvez Ruíz se encaminará firmemente a un eventual triunfo electoral en el 2024.
EL CARTÓN

Selva política Rugidos La frase del día
El gobernador de Nuevo León, Samuel García, al confirmar su interés de participar en la contienda de Movimiento Ciudadano para buscar la Presidencia de la República.
21 DE SEPTIEMBRE DE 2023 · SIE7E DE CHIAPAS 31 ESTATAL
“Mariana no me ha dado permiso para ir por la grande…”
EDITORIAL





JUEVES 21 DE SEP TIEMBRE DE 2023 · AÑO 12 · Nº. 4414 32 PÁGINAS · VALOR $7.00 WWW.SIE7EDECHIAPAS.COM